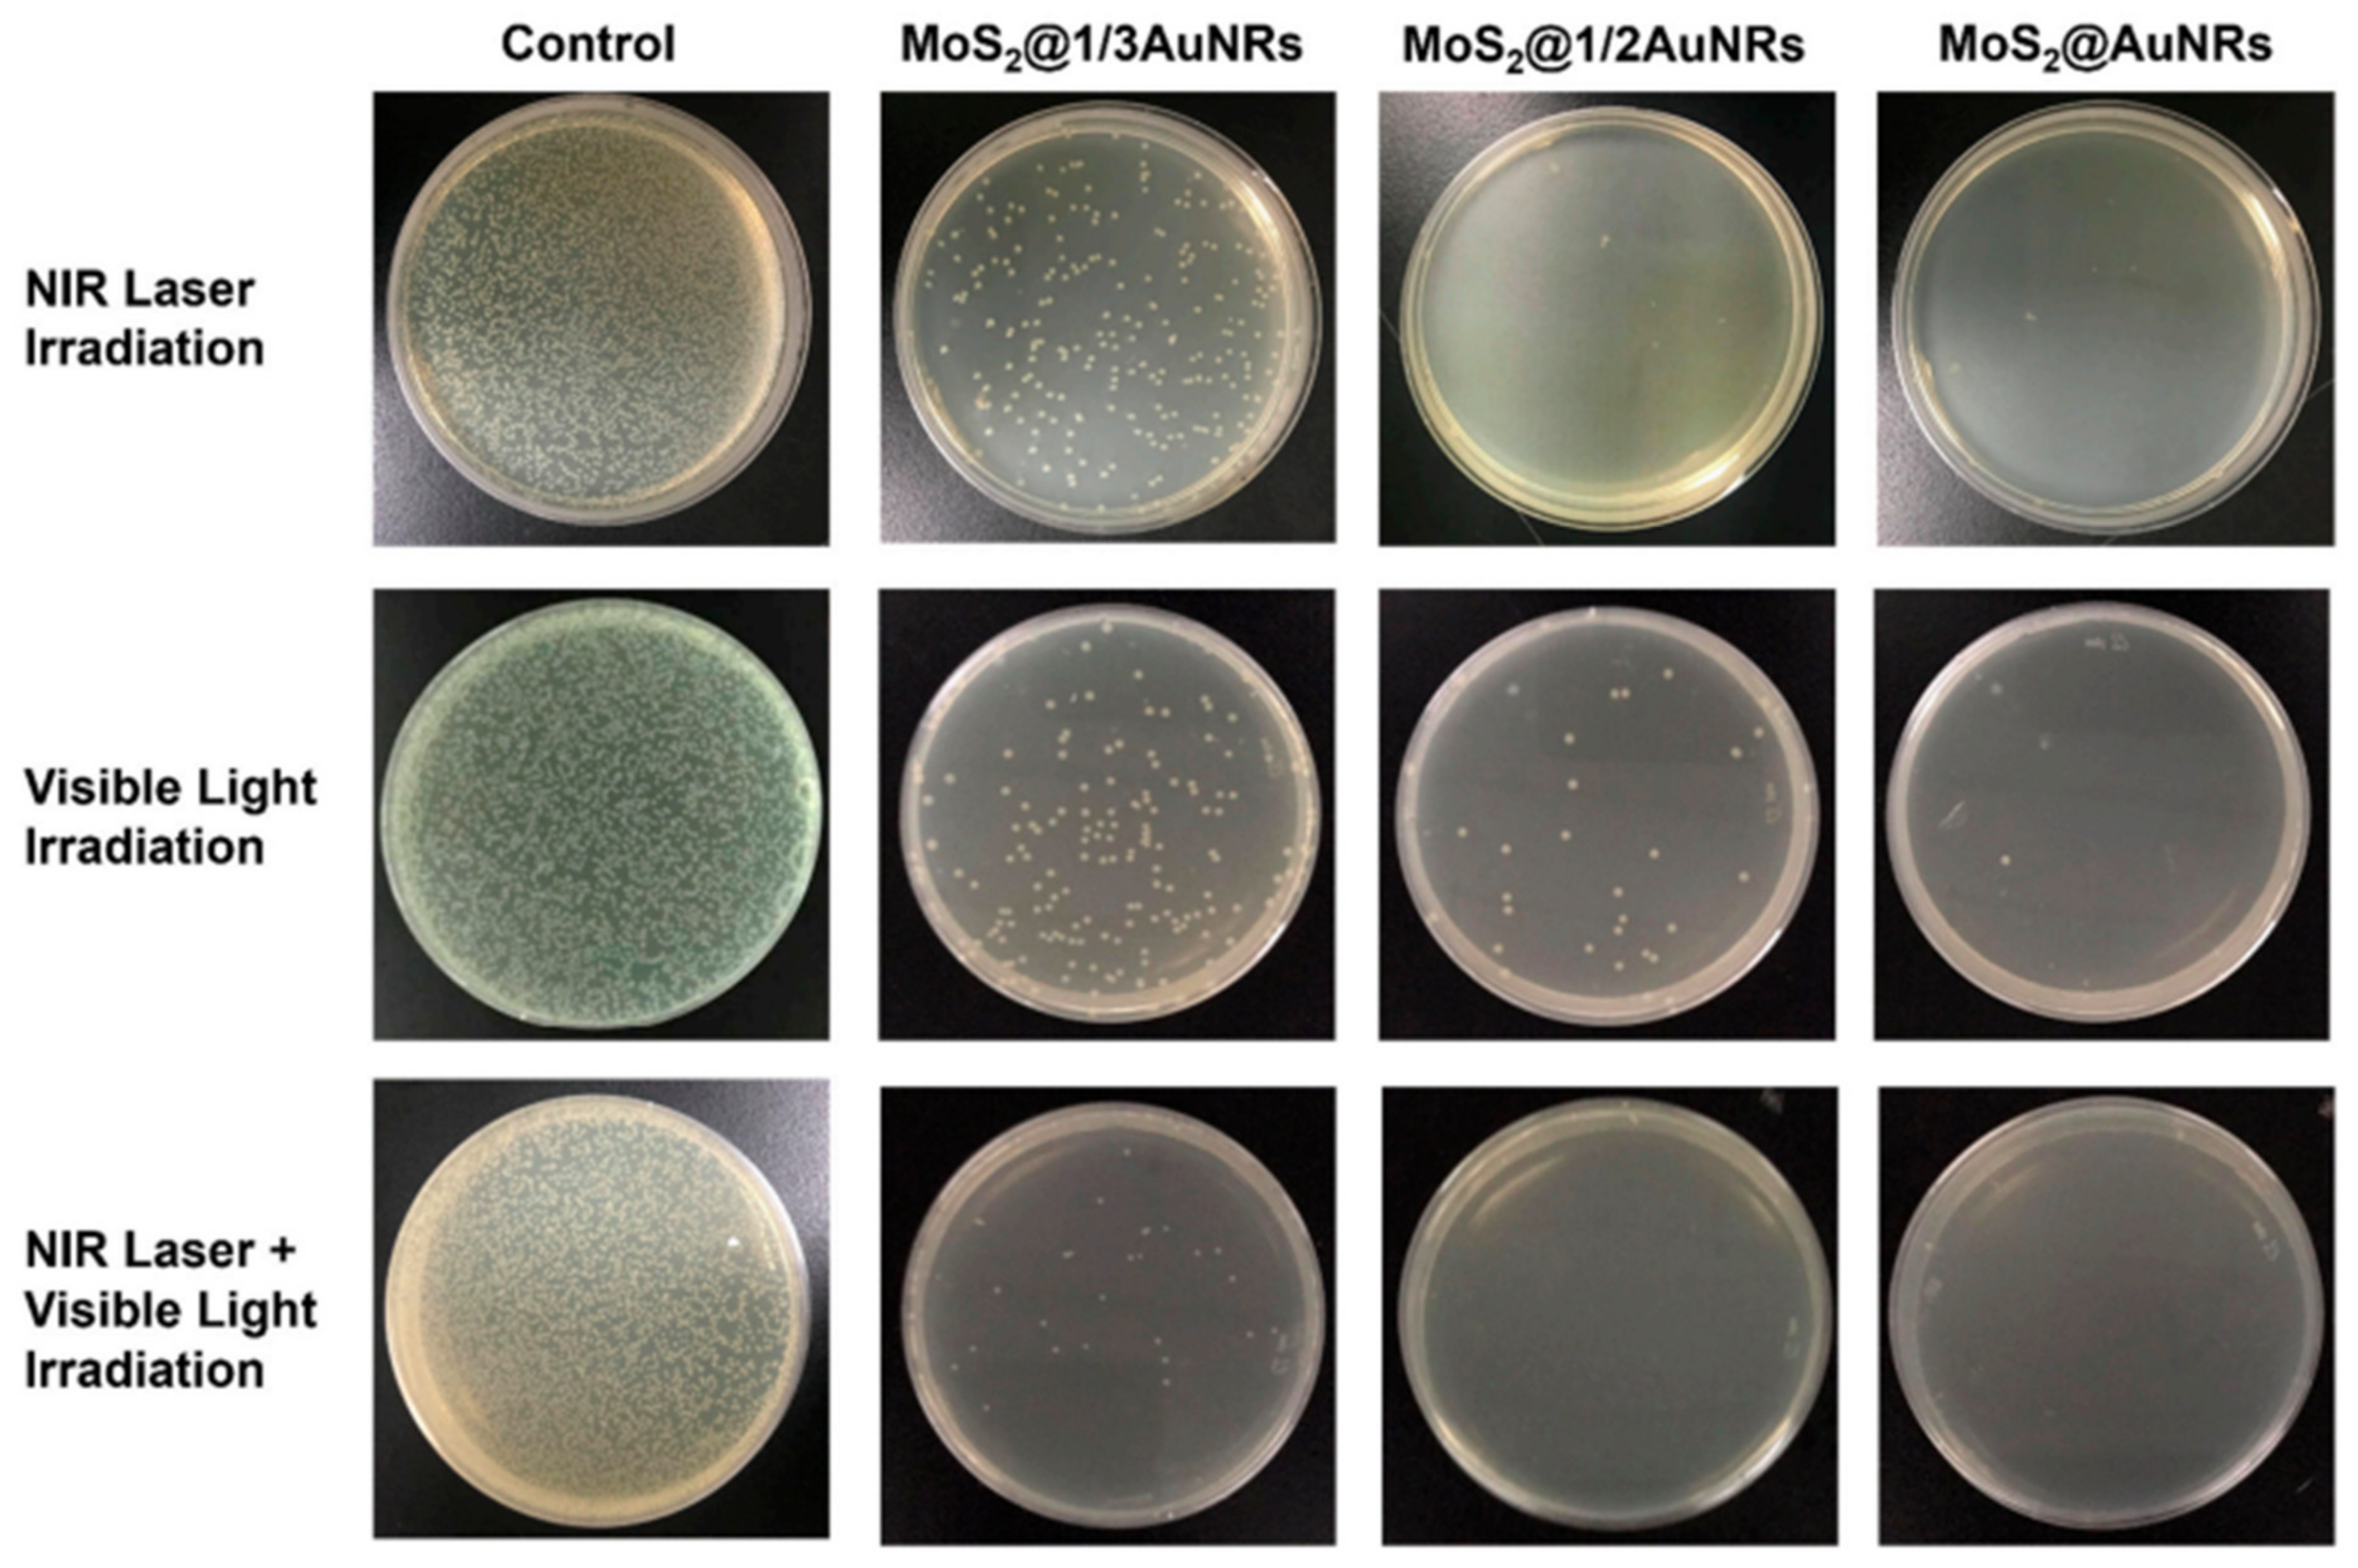
Ijms 25 05842 g015 Ijms 25 05842 g015

Nanoformulations in Pharmaceutical and Biomedical Applications: Green Perspectives
Abstract
1. Introduction
2. The Main Categories of Commonly Used Nanopharmaceuticals
2.1. Nanomicelles
2.2. Lipid-Based Nanoparticles
2.3. Liposomes
2.4. Dendrimers
2.5. Carbon Nanomaterials in Nanopharmaceutical Applications
2.5.1. Fullerenes
2.5.2. Carbon Nanotubes (CNTs)
2.5.3. Carbon Nanohorns
2.6. Metal-Based Nanopharmaceuticals
2.6.1. Metal and Metal Oxide Nanoparticles
2.6.2. Quantum Dots
2.6.3. MOFs (Metal–Organic Frameworks) in Biomedical Applications
2.7. Bio-Nanopharmaceuticals
2.7.1. Red Blood Cells (RBCs)
2.7.2. Prebiotics, Probiotics, and Postbiotics in Nanopharmaceuticals
- Maintaining a healthy microflora of the digestive system.
- Regulating digestion.
- Exhibiting anti-carcinogenic activity.
- Reducing cholesterol levels in the blood.
- Stimulating the immune system.
3. Current Trends in Modern Nanopharmaceuticals´ Design
3.1. Nanosuspension Technology
3.2. Nano-Encapsulation
3.3. Three-Dimensional Printing in Nanopharmacy (NanoPrinting)
3.3.1. Fundamentals of 3D Printing
3.3.2. Synthesis of Nanopharmaceuticals via 3D Printing
3.3.3. Applications in Drug Delivery Systems
3.3.4. Personalized Medicine and Patient-Specific Formulations
3.4. Biomimetics and Bioinspiration in Nanopharmaceuticals/Nanomedicines
3.4.1. Targeted Drug Delivery
- Biological Targeting Ligands: Bioinspired nanomedicines utilize targeting ligands, such as antibodies, peptides, or aptamers, that recognize and bind to specific molecular markers overexpressed on the surface of diseased cells. By mimicking the specificity of biological recognition processes, these nanocarriers can selectively deliver drugs to the site of action, sparing healthy tissues and minimizing systemic toxicity [290].
- Cellular Membrane Camouflage: Biomimetic nanocarriers can cloak themselves with cell-membrane-derived vesicles, mimicking the surface properties of host cells. This camouflage allows the nanocarriers to evade immune recognition and clearance while promoting interactions with target cells. These bioinspired nanomedicines enhance targeted drug delivery efficiency across biological barriers by leveraging endogenous cellular uptake mechanisms [291].
- Exosome-Mimetic Nanovesicles: Exosomes, natural extracellular vesicles secreted by cells, are carriers for intercellular communication and cargo transport. Bioinspired nanomedicines replicate exosomes’ structural and functional properties to achieve targeted drug delivery. Engineered nanovesicles resembling exosomes can exploit endocytic pathways and cell-to-cell interactions, facilitating specific drug delivery to recipient cells or tissues [292].
- Biological Barriers’ Penetration: Nature-inspired nanomedicines are designed to navigate biological barriers, such as the blood–brain barrier (BBB) or tumor microenvironment, to reach their intended targets. By mimicking biological entities’ size, shape, and surface properties, these nanocarriers can traverse cellular membranes and penetrate tissue barriers more efficiently, enabling effective drug delivery to otherwise inaccessible sites [293].
- Stimuli-Responsive Targeting: Bioinspired nanomedicines incorporate stimuli-responsive elements that enable a triggered drug release in response to specific biological cues. For example, pH-sensitive nanocarriers can selectively release their cargo in acidic microenvironments, exploiting the tumor’s acidic pH to trigger drug release. Similarly, enzyme-responsive nanocarriers can respond to enzymatic activity characteristics of certain diseases, allowing precise control over drug delivery kinetics [264].
3.4.2. Biological Barriers’ Penetration
- Cellular Membrane Interactions: Biological membranes serve as formidable barriers that regulate the entry of molecules into cells. Bioinspired nanomedicines leverage interactions with cellular membranes to facilitate the uptake and intracellular delivery of therapeutic payloads. By mimicking the surface properties and recognition mechanisms of biological entities, such as viruses or extracellular vesicles, nanocarriers can enhance cellular internalization and trafficking to target organelles or cellular compartments [294].
- Endocytic Pathways’ Exploitation: Cells employ endocytic pathways to internalize extracellular materials, including nanoparticles, through clathrin-mediated endocytosis, caveolae-mediated endocytosis, or macropinocytosis—bioinspired nanomedicines design strategies to exploit these endocytic mechanisms for efficient cellular uptake and intracellular drug delivery. By mimicking the endogenous cargoes’ size, shape, and surface properties, such as exosomes or viral particles, nanocarriers can hijack specific endocytic pathways to traverse cellular membranes and access the intracellular space [295].
- Blood–Brain Barrier (BBB) Penetration: The BBB presents a formidable obstacle to drug delivery to the central nervous system (CNS), restricting the passage of therapeutics into the brain parenchyma. Bioinspired nanomedicines mimic the properties of endogenous molecules that traverse the BBB, such as specific peptides or transport proteins, to facilitate brain-targeted drug delivery. Additionally, engineered nanocarriers can exploit receptor-mediated transcytosis or bypass mechanisms to penetrate the BBB while maintaining therapeutic efficacy and minimizing neurotoxicity [296].
- Tumor Microenvironment Permeation: The complex tumor microenvironment poses significant challenges for drug delivery, including heterogeneous blood vessel distribution, elevated interstitial fluid pressure, and dense extracellular matrix components. Bioinspired nanomedicines are designed to navigate these obstacles by mimicking the behavior of leukocytes or other cells that extravasate into tumors. Strategies such as surface modification with cell-adhesion molecules or matrix-degrading enzymes enable nanocarriers to penetrate tumor tissues, enhancing drug accumulation and distribution within the tumor microenvironment [297].
- Mucus Barrier Overcoming: Mucus layers lining mucosal surfaces, such as the respiratory, gastrointestinal, and reproductive tracts, act as protective barriers that limit the penetration of foreign particles, including nanoparticles. Bioinspired nanomedicines draw inspiration from mucolytic enzymes or mucoadhesive molecules found in nature to overcome mucus barriers. Nanocarriers can efficiently penetrate mucus layers by incorporating mucin-binding ligands or enzymatic degradation motifs, enabling targeted drug delivery to underlying tissues or cells [298].
3.4.3. Stealth and Biocompatibility
- Stealth Coating Mimicry: Many biological entities, such as red blood cells and specific pathogens, possess surface coatings that enable them to evade detection by the immune system. Inspired by these natural stealth mechanisms, researchers have developed stealth coatings for nanomedicines to prolong circulation time and reduce immune recognition. For example, PEG has been widely used as a biomimetic stealth coating because it forms a hydrated layer on nanoparticle surfaces, preventing opsonization and clearance by phagocytic cells [299].
- Cell Membrane Camouflage: Biomimetic nanocarriers can be engineered to mimic the surface properties of host cells, such as erythrocytes or leukocytes, through cell membrane coating strategies. By coating synthetic nanoparticles with cell membranes extracted from host cells, nanocarriers acquire a “self” identity that reduces immune recognition and enhances biocompatibility. Cell-membrane-camouflaged nanomedicines evade immune surveillance, exhibit prolonged circulation, and have improved targeting capabilities owing to their biological origin and surface composition [299]. RBC membrane-derived nanoparticles represent a promising platform for drug delivery and biomedical applications. Their inherent biocompatibility, stealth properties, and ability to encapsulate therapeutic payloads make them attractive candidates for targeted therapy against various diseases. However, scalability, safety, and regulatory approval pose significant hurdles in their clinical translation. Addressing these challenges through collaborative research efforts and rigorous preclinical testing is essential for harnessing the full potential of RBC membrane-derived nanoparticles in clinical practice.
- Biodegradable Materials Inspiration: Natural biomaterials with inherent biocompatibility and biodegradability, such as lipids, polysaccharides, and proteins, serve as inspiration for designing nanomedicines with a minimal toxicity and environmental impact. Bioinspired nanocarriers based on biodegradable polymers or lipid formulations mimic biological molecules’ structural and functional properties, ensuring compatibility with physiological systems and facilitating safe degradation and clearance from the body [300].
- Surface Modification with Natural Ligands: Nature provides a wealth of molecular motifs, such as glycoproteins and glycolipids, that mediate specific interactions with biological receptors and signaling pathways. Bioinspired nanomedicines leverage these natural ligands to modify nanoparticle surfaces, enabling targeted delivery and enhanced biocompatibility. By functionalizing nanocarriers with biomimetic ligands, such as carbohydrates or peptide sequences, researchers can achieve selective binding to cell surface receptors or extracellular matrix components, facilitating site-specific accumulation and uptake while minimizing off-target effects [299,300].
- Immunomodulatory Biomimetic Agents: Biological systems employ various immunomodulatory agents, such as cytokines and peptides, to regulate immune responses and maintain homeostasis. Bioinspired nanomedicines integrate immunomodulatory biomolecules into their design to modulate immune reactions and mitigate adverse immune responses. By mimicking the activity of endogenous immunoregulatory factors, such as anti-inflammatory cytokines or immunosuppressive peptides, nanocarriers can promote immune tolerance and enhance biocompatibility in vivo [300].
3.4.4. Responsive Drug Release
- pH-Responsive Nanocarriers: Biological environments, such as the acidic tumor microenvironment and the acidic compartments within cells, inspire pH-responsive drug delivery systems. Biomimetic nanocarriers engineered to respond to changes in pH exhibit altered physicochemical properties, such as protonation/deprotonation or structural transformations, leading to triggered drug release. By incorporating pH-sensitive moieties, such as acidic or basic functional groups, into nanocarrier formulations, researchers can exploit pH gradients to achieve site-specific drug delivery and enhance therapeutic efficacy while minimizing off-target effects [302].
- Enzyme-Responsive Nanoparticles: Biological systems utilize enzymes for many physiological processes, making them attractive targets for bioinspired drug delivery systems. Nanocarriers designed to respond to specific enzymatic activities can selectively release their cargo in the presence of disease-associated enzymes, such as proteases or nucleases. Researchers can achieve triggered drug release at disease sites by incorporating enzyme-cleavable linkers or substrates into nanocarrier formulations, enabling precise spatiotemporal control over therapeutic interventions and minimizing systemic toxicity [303].
- Temperature-Responsive Nanoparticles: Inspired by thermoresponsive polymers found in nature, researchers have developed temperature-responsive hydrogels for controlled drug delivery applications. These biomimetic hydrogels undergo reversible phase transitions in response to changes in temperature, leading to triggered drug release. By tuning the lower critical solution temperature (LCST) of thermoresponsive polymers, nanocarriers can be designed to release drugs upon exposure to physiological or external heat stimuli, offering on-demand drug delivery with enhanced spatial and temporal control [304]. Heating-induced drug release systems are an innovative and versatile approach in nanomedicine, utilizing various materials that respond to thermal stimuli to achieve controlled and targeted therapeutic delivery. Certain polymers exhibit temperature-sensitive behavior, undergoing phase transitions or changes in solubility at specific temperatures. Polymers like poly(N-isopropylacrylamide) (PNIPAM) transition from a hydrophilic to a hydrophobic state at their lower critical solution temperature (LCST), leading to drug release [305]. These polymeric nanoparticles can be engineered to release drugs when the local temperature is raised. Metal nanoparticles, such as gold nanoparticles and magnetic nanoparticles, can be used to induce localized heating through photothermal or magnetic hyperthermia effects. When these nanoparticles are exposed to laser light (typically near-infrared) or an alternating magnetic field, they generate heat, which can trigger the release of drugs from nanocarriers or directly ablate cancer cells. Mesoporous silica nanoparticles (MSNPs) can be functionalized with thermoresponsive polymers or capped with heat-sensitive molecules. Upon heating, these caps detach or the polymer changes its configuration, allowing the release of the drug molecules stored within the nanopores [306].
- Light-Responsive Nanoparticles: Nature-inspired light-responsive nanocarriers leverage photoreactive molecules or photosensitive materials to achieve spatiotemporal control over drug release using light as an external stimulus. Inspired by photosensitive proteins and pigments in biological systems, such as photoreceptors and chlorophyll, researchers have engineered nanocarriers that undergo photothermal, photochemical, or photophysical transformations upon light exposure, leading to triggered drug release. Light-responsive nanomedicines offer non-invasive, remote-controlled drug delivery modalities with high spatial precision and tunable release kinetics [257].
- Magnetic and Ultrasound-Responsive Nanoparticles: Biomimetic nanocarriers can be engineered to respond to external physical stimuli, such as magnetic fields or ultrasound waves, for triggered drug release. Inspired by the navigational abilities of magnetotactic bacteria and the tissue-penetrating capabilities of ultrasound contrast agents, researchers have developed magnetic and ultrasound-responsive nanomedicines capable of site-specific drug delivery and release under controlled external conditions. Researchers can achieve targeted drug release with spatiotemporal precision and minimal invasiveness by incorporating magnetic nanoparticles or ultrasound-responsive materials into nanocarrier formulations [307].
- ROS-responsive nanocarriers: Oxidative stress (i.e., the imbalance between oxidants and antioxidants in favor of the first ones mentioned) has been found to be elevated in the pathogenesis of many diseases. Thus, another type of stimuli-responsive nanocarriers have been developed—the redox-responsive nanocarriers. The ROS levels are higher in tumor microenvironments than in normal tissues [301].
3.4.5. Theranostic Capabilities
- Multifunctional Nanoparticles: Inspired by the multifunctionality of biological entities, such as cells and viruses, multifunctional nanoparticles have been developed for theranostic applications. These nanocarriers integrate diagnostic imaging agents, such as contrast agents or fluorescent probes, with therapeutic payloads, allowing for real-time drug delivery and therapeutic response monitoring. By encapsulating imaging agents and drugs within a single nanocarrier platform, researchers can achieve targeted delivery to disease sites while simultaneously visualizing drug distribution and pharmacokinetics in vivo [316].
- Targeted Imaging and Therapy: Biomimetic targeting strategies, inspired by the specific interactions observed in biological systems, enable the precise delivery of theranostic agents to diseased tissues or cells. Functionalizing nanocarriers with targeting ligands, such as antibodies or peptides, allows for selective binding to molecular markers overexpressed on diseased cells, enhancing imaging contrast and therapeutic efficacy. By combining targeted imaging with localized drug release, theranostic nanomedicines enable personalized medicine approaches tailored to individual patient profiles, optimizing treatment outcomes while minimizing off-target effects [317].
- Responsive Theranostic Platforms: Nature-inspired stimuli-responsive nanocarriers offer dynamic control over diagnostic imaging and therapeutic release in response to specific physiological cues or external stimuli. Researchers can achieve the triggered release of imaging agents and drugs at disease sites by incorporating stimuli-responsive polymers or nanomaterials, such as pH-sensitive polymers or temperature-sensitive liposomes, enabling spatiotemporal control over theranostic interventions. Responsive theranostic platforms can monitor disease progression in real time and adapt treatment strategies accordingly, enhancing therapeutic efficacy and patient outcomes [318].
- Integrated Imaging Modalities: Inspired by the integrated sensing capabilities of biological organisms, theranostic nanomedicines incorporate a diverse range of imaging modalities for comprehensive disease diagnosis and monitoring. From traditional imaging techniques, such as MRI and PET, to emerging modalities, such as photoacoustic imaging and surface-enhanced Raman scattering (SERS), integrated imaging platforms provide complementary information on disease pathology and treatment response. By combining multiple imaging modalities within a single nanocarrier system, researchers can achieve synergistic diagnostic capabilities and improve the accuracy of disease detection and treatment monitoring [319,320,321,322,323,324].
- Personalized Theranostics: Biomimetic design principles enable the development of personalized theranostic approaches tailored to individual patient characteristics and disease profiles [323]. By leveraging patient-specific imaging data and molecular biomarkers, theranostic nanomedicines can be customized to target specific disease subtypes or molecular signatures, optimizing treatment selection and response prediction [314]. Personalized therapeutics hold promise for guiding precision medicine strategies, enabling the early detection of disease recurrence, facilitating timely therapeutic interventions, and ultimately improving patient outcomes and quality of life [324].
3.4.6. Green Design
4. Nanopharmaceuticals in Photo-Based Treatments
5. NanoTheranostic Agents
6. Challenges and Limitations of Nanopharmaceuticals
7. Nanopharmaceuticals’ Testing
- (i)
- In vitro cell and tissue cultures—routinely used for the preliminary screening of potential drug toxicity and involves the in vitro growth of animal/human cells outside the body in the laboratory environment;
- (ii)
- Microbiological systems such as prokaryotes (e.g., Escherichia coli) and fungi (e.g., Saccharomyces cerevisiae, Aspergillus nidulans);
- (iii)
- Stem cells—toxicological tests involving the insertion of disease genes into embryonic stem cells, which then differentiate into human disease tissues that can be further used for drug screening;
- (iv)
- Invertebrate organisms—such as Drosophila melanogaster, Hydra, and others;
- (v)
- Lower vertebrates such as zebrafish (Danio rerio)—an attractive option due to the genetic relatedness to higher vertebrates including mammals;
- (vi)
- Plant-tissue based material—studies on the effect of nanopharmaceuticals on the environment performed on Brassica juncea, resulting in drug-induced defense responses and the activation of the detoxification mechanism;
- (vii)
- DNA chips—glass slides with an array of genes or DNA fragments that enable the pharmacogenetics studies;
- (viii)
- Microfluidics—a series of tiny compartments each containing tissue samples (originating from different body parts) and linked by microchannels through which flows a blood substitute in which the test drug it is introduced;
- (ix)
- Computer analysis models—in silico experiments on computer-generated simulations by using various softwares such as the Computer-Aided Drug Design (CADD, used to predict the receptor-binding site for a potential drug) and the Quantitative Structure–Activity Relationship (QSAR, used to predict the carcinogenicity);
- (x)
8. Future Directions and Concluding Remarks
Author Contributions
Funding
Conflicts of Interest
Abbreviations and Symbols
| AgNPs | Silver nanoparticles |
| AuNCs | Gold nanocubes |
| AuNPs | Gold nanoparticles |
| AuNRs | Gold nanorods |
| AuS | Gold shell |
| AZO | Azobenzene |
| Bac | Bifidobacterium |
| BBB | Blood–Brain Barrier |
| BSA | Bovine serum albumin |
| CAD | Computer-aided design |
| CBNs | Carbon-based nanomaterials |
| CDT | Chemo-dynamic therapy |
| CeO2 NPs | Cerium oxide nanoparticles |
| Chl | Chlorophyll |
| Ce6 | Chlorin e6 |
| CMC | Critical micellar concentration |
| CNMs | Carbon nanomaterials |
| CNHs | Carbon nanohorns or carbon nanocons |
| CNS | Central nervous system |
| CNTs | Carbon nanotubes |
| CS | Chitosan |
| CSNCs | Chitosan nanocapsules |
| CT | Computed tomography |
| CuO NPs | Copper-oxide nanoparticles |
| CUR | Curcumin |
| DDS | Drug Delivery System |
| DLS | Dynamic Light Scattering |
| DNA | Deoxyribonucleic acid |
| DNPs | Diatom nanoparticles |
| DoE | Design of experiments |
| DOX | Doxorubicin |
| DPA-QDs | D-penicillamine-coated quantum dots |
| DWCNTs | Double-walled carbon nanotubes |
| EM | E. coli-derived membrane |
| EMA | European Medicines Agency |
| EO | Essential oils |
| EPR | Enhanced permeability and retention effect |
| EVs | Extracellular vesicles |
| FDA | United States Food and Drug Administration |
| Fe2O3NPs | Iron-oxide nanoparticles |
| FTIR | Fourier-transform infrared spectroscopy |
| 5-FU | 5-Fluorouracil |
| GI | Gastrointestinal |
| GLP-1 | Glucagon-like peptide 1 |
| GSH | Glutathione |
| HspG41C | Mutant heat-shock protein (Hsp) cage, in which the Glycine from position 41 was replaced by a Cysteine residue |
| Hyp-AuNP | Gold Nanoparticles conjugated with Hypericin |
| ICG | Indocyanine green dye |
| ICH | International Council for Harmonization of Technical Requirements for Pharmaceuticals for Human Use |
| ICG | Indocyanine green dye |
| JNK | c-Jun N-terminal kinase |
| LB | Luria Bretani agar |
| LCP | L. casei postbiotics |
| LCST | Lower critical solution temperature |
| LNPs | Lipid nanoparticles |
| MHAp | Magnetic hydroxyapatite |
| MHNRs | Magnetic hydroxyapatite nanorods |
| MHT | Magnetic hyperthermia |
| MNPs | Metallic nanoparticles |
| MOFs | Metal–organic frameworks |
| MONPs | Metal-oxide nanoparticles |
| MoS2@AuNR | Gold Nanorod-Decorated Metallic MoS2 Nanosheets |
| MPFVs | Minimally processed fruits and vegetables |
| MRI | Magnetic resonance imaging |
| MSNPs | Mesoporous silica nanoparticles |
| MUG-Mel2 | Melanoma skin cancer cells |
| MWCNTs | Multi-walled carbon nanotubes |
| NDFs | Nanoscale dietary fibers |
| NGPs | Next-generation probiotics |
| NIR | Near-infrared |
| NLCs | Nanostructured lipid carriers |
| NPs | Nanoparticles |
| NRF2 | Nuclear factor erythroid 2–related factor 2 |
| NTs | Nanotubes |
| OMV | Outer membrane vesicles |
| OVA | Ovalbumin |
| P38 MAPK | p38 mitogen-activated protein kinases |
| PAA | Poly(acrylic acid) |
| PAA-Pt | Poly(acrylic acid) (PAA)-protected platinum nanoparticle species |
| PBT | Persistent, Bioaccumulative, and Toxic |
| PCE | Photothermal conversion efficiency |
| PCL | Poly(ε-caprolactone) |
| PDT | Photodynamic therapy |
| PdNPs | Palladium Nanoparticles |
| PEG | Poly(ethylene glycol) |
| PET | Positron Emission Tomography |
| PLA | Poly(lactic acid) |
| PLGA | Poly(lactic-co-glycolic acid) |
| P127 | Pluronic F127 |
| PNIPAM | Poly(N-isopropylacrylamide) |
| PS | Photosensitizer |
| PtNPs | Platinum nanoparticles |
| PTT | Photothermal therapy |
| PVA | Poly(vinyl alcohol) |
| QDs | Quantum dots |
| RBCs | Red Blood Cells |
| RGD | Arginyl-glycyl-aspartic acid (Arg-Gly-Asp, R: arginine; G: glycine; D: aspartic acid) |
| RNA | Ribonucleic acid |
| ROS | Reactive Oxygen Species |
| RWE | Real-world evidence |
| SCC-25 | Squamous cell carcinoma |
| SCFA | Short-chain fatty acids |
| SEM | Scanning Electron Microscopy |
| SeM | Diselenide-bridged mesoporous silica nanoparticles |
| SeNPs | Selenium nanoparticles |
| SERS | Surface-enhanced Raman scattering |
| SLA | Stereolithography |
| SLNs | Solid lipid nanoparticles |
| SLS | Selective laser sintering |
| SNEDDS | Self-nanoemulsifying drug delivery systems |
| SOD | Superoxide dismutase |
| SPECT | Single-photon emission computed tomography |
| srNPs | Stimuli responsive nanoparticles |
| SUVs | Small unilamellar lipid vesicles |
| SWCNTs | Single-walled carbon nanotubes |
| SWCNHs | Single-walled carbon nanohorns |
| TiO2 NPs | Titanium oxide nanoparticles |
| UC | Ulcerative colitis |
| ZHTC@IR780 | Zein/hyaluronic acid (HA)/tannin (TA)/Cu2+ loaded with IR780 |
| ZnO NPs | Zinc-oxide nanoparticles |
References
- Zhu, S.; Zeng, M.; Feng, G.; Wu, H. Platinum Nanoparticles As A Therapeutic Agent Against Dextran Sodium Sulfate-Induced Colitis In Mice. Int. J. Nanomed. 2019, 14, 8361–8378. [Google Scholar] [CrossRef] [PubMed]
- Gurunathan, S.; Jeyaraj, M.; Kang, M.-H.; Kim, J.-H. Anticancer Properties of Platinum Nanoparticles and Retinoic Acid: Combination Therapy for the Treatment of Human Neuroblastoma Cancer. Int. J. Mol. Sci. 2020, 21, 6792. [Google Scholar] [CrossRef] [PubMed]
- Zandi, M.; Fazeli, M.; Bigdeli, R.; Asgary, V.; Cohan, R.A.; Bashar, R.; Shahmahmoodi, S. Preparation of cerium oxide nanoparticles and their cytotoxicity evaluation in vitro and in vivo. Int. J. Med. Toxicol. Forensic Med. 2022, 12, 35374. [Google Scholar] [CrossRef]
- Ulker, D.; Abacioglu, N.; Sehirli, A.O. Cerium Oxide (CeO2) Nanoparticles Could Have Protective Effect Against COVID-19. Lett. Appl. NanoBioSci. 2022, 12, 12. [Google Scholar] [CrossRef]
- Kontham, S.; Mandava, K.; Dosa, S.; Mohd, F.U.; Mohammed, O.A.; Mohammad, A.U. Review on facile synthesis of cerium oxide nanoparticles and their biomedical applications. Inorg. Nano-Met. Chem. 2022, 52, 1183–1195. [Google Scholar] [CrossRef]
- Rzigalinski, B.A.; Carfagna, C.S.; Ehrich, M. Cerium oxide nanoparticles in neuroprotection and considerations for efficacy and safety. Wiley Interdiscip. Rev. Nanomed. Nanobiotechnol. 2017, 9, e1444. [Google Scholar] [CrossRef]
- Nosrati, H.; Heydari, M.; Khodaei, M. Cerium oxide nanoparticles: Synthesis methods and applications in wound healing. Mater. Today. Bio 2023, 23, 100823. [Google Scholar] [CrossRef]
- Ziental, D.; Czarczynska-Goslinska, B.; Mlynarczyk, D.T.; Glowacka-Sobotta, A.; Stanisz, B.; Goslinski, T.; Sobotta, L. Titanium Dioxide Nanoparticles: Prospects and Applications in Medicine. Nanomaterials 2020, 10, 387. [Google Scholar] [CrossRef] [PubMed]
- Zhang, J.; Shi, J.; Han, S.; Zheng, P.; Chen, Z.; Jia, G. Titanium dioxide nanoparticles induced reactive oxygen species (ROS) related changes of metabolomics signatures in human normal bronchial epithelial (BEAS-2B) cells. Toxicol. Appl. Pharmacol. 2022, 444, 116020. [Google Scholar] [CrossRef] [PubMed]
- Subramanian, R.; Ponnanikajamideen, M.; Samuel Rajendran, R.; Alshehri, M.A.; Alasmari, A.; Panneerselvam, C.; Periyasamy, S. TiO2 nanoparticles: Green synthesis, characterization, and investigation of antimicrobial properties, and developmental toxicity in zebrafish (Danio rerio) embryos. Drug Chem. Toxicol. 2024, 47, 90–100. [Google Scholar] [CrossRef] [PubMed]
- Erenler, R.; Gecer, E.N.; Hosaflioglu, I.; Behcet, L. Green synthesis of silver nanoparticles using Stachys spectabilis: Identification, catalytic degradation, and antioxidant activity. Biochem. Biophys. Res. Commun. 2023, 659, 91–95. [Google Scholar] [CrossRef] [PubMed]
- Vijapur, L.S.; Srinivas, Y.; Desai, A.R.; Gudigennavar, A.S.; Shidramshettar, S.L.; Yaragattimath, P. Development of biosynthesized silver nanoparticles from Cinnamomum tamala for anti-oxidant, anti-microbial and anti-cancer activity. J. Res. Pharm. 2023, 27, 769. [Google Scholar] [CrossRef]
- Narde, J.; Ahmed, N.; Maiti, S.; Rajeshkumar, S.; Ganapathy, D. Green Synthesis of Silver Nanoparticles from Aloe Vera and Neem Leaf Extract and their Cytotoxic Effect evaluation. J. Popul. Ther. Clin. Pharmacol. 2023, 30, 174–180. [Google Scholar] [CrossRef]
- Marassi, V.; Di Cristo, L.; Smith, S.G.J.; Ortelli, S.; Blosi, M.; Costa, A.L.; Reschiglian, P.; Volkov, Y.; Prina-Mello, A. Silver nanoparticles as a medical device in healthcare settings: A five-step approach for candidate screening of coating agents. R. Soc. Open Sci. 2018, 5, 171113. [Google Scholar] [CrossRef] [PubMed]
- Barbinta-Patrascu, M.-E.; Badea, N.; Bacalum, M.; Ungureanu, C.; Suica-Bunghez, I.R.; Iordache, S.M.; Pirvu, C.; Zgura, I.; Maraloiu, V.A. 3D hybrid structures based on biomimetic membranes and Caryophyllus aromaticus—“Green” synthesized nano-silver with improved bioperformances. Mater. Sci. Eng. C-Mater. Biol. Appl. 2019, 101, 120–137. [Google Scholar] [CrossRef] [PubMed]
- Barbinta-Patrascu, M.-E.; Gorshkova, Y.; Ungureanu, C.; Badea, N.; Bokuchava, G.; Lazea-Stoyanova, A.; Bacalum, M.; Zhigunov, A.; Petrovic, S. Characterization and Antitumoral Activity of Biohybrids Based on Turmeric and Silver/Silver Chloride Nanoparticles. Materials 2021, 14, 4726. [Google Scholar] [CrossRef] [PubMed]
- Geszke-Moritz, M.; Moritz, M. Quantum dots as versatile probes in medical sciences: Synthesis, modification and properties. Mater. Sci. Eng. C Mater. Biol. Appl. 2013, 33, 1008–1021. [Google Scholar] [CrossRef]
- Rocha, T.L.; Mestre, N.C.; Sabóia-Morais, S.M.T.; Bebianno, M.J. Environmental behaviour and ecotoxicity of quantum dots at various trophic levels: A review. Environ. Int. 2017, 98, 1–17. [Google Scholar] [CrossRef]
- Jiang, X.; Rocker, C.; Hafner, M.; Brandholt, S.; Dorlich, R.M.; Nienhaus, G.U. Endo-and exocytosis of zwitterionic quantum dot nanoparticles by live HeLa cells. ACS Nano 2010, 4, 6787–6797. [Google Scholar] [CrossRef] [PubMed]
- Bonilla, C.A.M.; Kouznetsov, V.V. “Green” Quantum Dots: Basics, Green Synthesis, and Nanotechnological Applications; IntechOpen Limited: London, UK, 2016. [Google Scholar] [CrossRef]
- Ding, M.; Liu, W.; Gref, R. Nanoscale MOFs: From synthesis to drug delivery and theranostics applications. Adv. Drug Deliv. Rev. 2022, 190, 114496. [Google Scholar] [CrossRef] [PubMed]
- Rao, C.; Liao, D.; Pan, Y.; Zhong, Y.; Zhang, W.; Ouyang, Q.; Alireza, N.E.; Liu, J. Novel formulations of metal-organic frameworks for controlled drug delivery. Expert Opin. Drug Deliv. 2022, 19, 1183–1202. [Google Scholar] [CrossRef]
- Livesey, T.C.; Mahmoud, L.A.M.; Katsikogianni, M.G.; Nayak, S. Metal–Organic Frameworks and Their Biodegradable Composites for Controlled Delivery of Antimicrobial Drugs. Pharmaceutics 2023, 15, 274. [Google Scholar] [CrossRef] [PubMed]
- Yang, H.; Liao, D.; Cai, Z.; Zhang, Y.; Nezamzadeh-Ejhieh, A.; Zheng, M.; Liu, J.; Bai, Z.; Song, H. Current status of Fe-based MOFs in biomedical applications. RSC Med. Chem. 2023, 14, 2473–2495. [Google Scholar] [CrossRef] [PubMed]
- Christodoulou, I.; Lyu, P.; Soares, C.V.; Patriarche, G.; Serre, C.; Maurin, G.; Gref, R. Nanoscale Iron-Based Metal–Organic Frameworks: Incorporation of Functionalized Drugs and Degradation in Biological Media. Int. J. Mol. Sci. 2023, 24, 3362. [Google Scholar] [CrossRef] [PubMed]
- Ibrahim, M.R.; Greish, Y.E. MOF-Based Biosensors for the Detection of Carcinoembryonic Antigen: A Concise Review. Molecules 2023, 28, 5970. [Google Scholar] [CrossRef] [PubMed]
- Niu, H.; Bu, H.; Zhao, J.; Zhu, Y. Metal-Organic Frameworks-Based Nanoplatforms for the Theranostic Applications of Neurological Diseases. Small 2023, 19, e2206575. [Google Scholar] [CrossRef] [PubMed]
- Xiong, K.; Wei, F.; Chen, Y.; Ji, L.; Chao, H. Recent Progress in Photodynamic Immunotherapy with Metal-Based Photosensitizers. Small Methods 2023, 7, 2201403. [Google Scholar] [CrossRef]
- Tang, Y.; Han, Y.; Zhao, J.; Lv, Y.; Fan, C.; Zheng, L.; Cheng, L.; Lin, Y. A Rational Design of Metal–Organic Framework Nanozyme with High-Performance Copper Active Centers for Alleviating Chemical Corneal Burns. Nano-Micro Lett. 2023, 15, 112. [Google Scholar] [CrossRef]
- Chen, J.; Liu, J.; Yaping Hu, Y.; Tian, Z.; Zhu, Y. Metal-organic framework-coated magnetite nanoparticles for synergistic magnetic hyperthermia and chemotherapy with pH-triggered drug release. Sci. Technol. Adv. Mater. 2019, 20, 1043–1054. [Google Scholar] [CrossRef]
- Kashyap, B.K.; Singh, V.V.; Solanki, M.K.; Kumar, A.; Ruokolainen, J.; Kesari, K.K. Smart Nanomaterials in Cancer Theranostics: Challenges and Opportunities. ACS Omega 2023, 8, 14290–14320. [Google Scholar] [CrossRef] [PubMed]
- Do, H.H.; Truong, H.B. Ni, Co, Zn, and Cu metal-organic framework-based nanomaterials for electrochemical reduction of CO2: A review. Beilstein J. Nanotechnol. 2023, 14, 904–911. [Google Scholar] [CrossRef] [PubMed]
- Ding, S.; O’Banion, C.P.; Welfare, J.G.; Lawrence, D.S. Cellular Cyborgs: On the Precipice of a Drug Delivery Revolution. Cell Chem. Biol. 2018, 25, 648–658. [Google Scholar] [CrossRef] [PubMed]
- Fakhrullin, R.F.; Zamaleeva, A.I.; Minullina, R.T.; Konnova, S.A.; Paunov, V.N. Cyborg cells: Functionalisation of living cells with polymers and nanomaterials. Chem. Soc. Rev. 2012, 41, 4189. [Google Scholar] [CrossRef] [PubMed]
- Ariga, K.; Fakhrullin, R. Nanoarchitectonics on living cells. RSC Adv. 2021, 11, 18898–18914. [Google Scholar] [CrossRef]
- Hu, C.-M.J.; Fang, R.H.; Luk, B.T.; Zhang, L. Nanoparticle-detained toxins for safe and effective vaccination. Nat. Nanotechnol. 2013, 8, 933–938. [Google Scholar] [CrossRef]
- Sun, H.; Su, J.; Meng, Q.; Yin, Q.; Chen, L.; Gu, W.; Zhang, P.; Zhang, Z.; Yu, H.; Wang, S.; et al. Cancer-Cell-Biomimetic Nanoparticles for Targeted Therapy of Homotypic Tumors. Adv. Mater. 2017, 29, 1703698. [Google Scholar] [CrossRef] [PubMed]
- Gao, W.; Hu, C.-M.J.; Fang, R.H.; Luk, B.T.; Su, J.; Zhang, L. Surface Functionalization of Gold Nanoparticles with Red Blood Cell Membranes. Adv. Mater. 2013, 25, 3549–3553. [Google Scholar] [CrossRef]
- Parodi, A.; Quattrocchi, N.; van de Ven, A.L.; Chiappini, C.; Evangelopoulos, M.; Martinez, J.O.; Brown, B.S.; Khaled, S.Z.; Yazdi, I.K.; Enzo, M.V.; et al. Synthetic nanoparticles functionalized with biomimetic leukocyte membranes possess cell-like functions. Nat. Nanotechnol. 2013, 8, 61–68. [Google Scholar] [CrossRef]
- Fang, R.H.; Hu, C.-M.J.; Luk, B.T.; Gao, W.; Copp, J.A.; Tai, Y.; O’Connor, D.E.; Zhang, L. Cancer cell membrane-coated nanoparticles for anticancer vaccination and drug delivery. Nano Lett. 2014, 14, 2181–2188. [Google Scholar] [CrossRef] [PubMed]
- Hu, C.-M.J.; Zhang, L.; Aryal, S.; Cheung, C.; Fang, R.H.; Zhang, L. Erythrocyte membrane-camouflaged polymeric nanoparticles as a biomimetic delivery platform. Proc. Natl. Acad. Sci. USA 2011, 108, 10980–10985. [Google Scholar] [CrossRef]
- Luk, B.T.; Fang, R.H.; Hu, C.-M.J.; Copp, J.A.; Thamphiwatana, S.; Dehaini, D.; Gao, W.; Zhang, K.; Li, S.; Zhang, L. Safe and Immunocompatible Nanocarriers Cloaked in RBC Membranes for Drug Delivery to Treat Solid Tumors. Theranostics 2016, 6, 1004–1011. [Google Scholar] [CrossRef] [PubMed]
- Rao, L.; Bu, L.-L.; Xu, J.-H.; Cai, B.; Yu, G.-T.; Yu, X.; He, Z.; Huang, Q.; Li, A.; Guo, S.-S.; et al. Red Blood Cell Membrane as a Biomimetic Nanocoating for Prolonged Circulation Time and Reduced Accelerated Blood Clearance. Small 2015, 11, 6225–6236. [Google Scholar] [CrossRef] [PubMed]
- Wei, X.; Gao, J.; Wang, F.; Ying, M.; Angsantikul, P.; Kroll, A.V.; Zhou, J.; Gao, W.; Lu, W.; Fang, R.H.; et al. In Situ Capture of Bacterial Toxins for Antivirulence Vaccination. Adv. Mater. 2017, 29, 1701644. [Google Scholar] [CrossRef] [PubMed]
- That, L.F.L.N.; Kyereh, E.; Ansah, F.A.; Pandohee, J. Nanoencapsulated Probiotics and Prebiotics. In Handbook of Nanoencapsulation; CRC Press: Boca Raton, FL, USA, 2023; p. 191. [Google Scholar] [CrossRef]
- Ji, J.; Jin, W.; Liu, S.J.; Jiao, Z.; Li, X. Probiotics, prebiotics, and postbiotics in health and disease. MedComm 2023, 4, e420. [Google Scholar] [CrossRef] [PubMed]
- Campaniello, D.; Bevilacqua, A.; Speranza, B.; Racioppo, A.; Sinigaglia, M.; Corbo, M.R. A narrative review on the use of probiotics in several diseases. Evidence and perspectives. Front. Nutr. 2023, 10, 1209238. [Google Scholar] [CrossRef] [PubMed]
- Baral, K.C.; Bajracharya, R.; Lee, S.H.; Han, H.K. Advancements in the Pharmaceutical Applications of Probiotics: Dosage Forms and Formulation Technology. Int. J. Nanomed. 2021, 16, 7535–7556. [Google Scholar] [CrossRef] [PubMed]
- Xu, C.; Ban, Q.; Wang, W.; Hou, J.; Jiang, Z. Novel nano-encapsulated probiotic agents: Encapsulate materials, delivery, and encapsulation systems. J. Control. Release 2022, 349, 184–205. [Google Scholar] [CrossRef] [PubMed]
- Sun, Q.; Yin, S.; He, Y.; Cao, Y.; Jiang, C. Biomaterials and Encapsulation Techniques for Probiotics: Current Status and Future Prospects in Biomedical Applications. Nanomaterials 2023, 13, 2185. [Google Scholar] [CrossRef] [PubMed]
- Zhang, L.; Hu, Y.; Jiang, L.; Huang, H. Microbial Encapsulation and Targeted Delivery Mechanisms of Double Emulsion Loaded with Probiotics—A State-of-Art Review. Food Rev. Int. 2023, 1–25. [Google Scholar] [CrossRef]
- Lin, Q.; Si, Y.; Zhou, F.; Hao, W.; Zhang, P.; Jiang, P.; Cha, R. Advances in polysaccharides for probiotic delivery: Properties, methods, and applications. Carbohydr. Polym. 2024, 323, 121414. [Google Scholar] [CrossRef]
- Agriopoulou, S.; Tarapoulouzi, M.; Varzakas, T.; Jafari, S.M. Application of Encapsulation Strategies for Probiotics: From Individual Loading to Co-Encapsulation. Microorganisms 2023, 11, 2896. [Google Scholar] [CrossRef]
- Jumazhanova, M.; Kakimova, Z.; Zharykbasov, Y.; Kassymov, S.; Zhumadilova, G.; Muratbayev, A.; Tashybayeva, M.; Suychinov, A. Effect of the Encapsulation Process on the Viability of Probiotics in a Simulated Gastrointestinal Tract Model Medium. Processes 2023, 11, 2757. [Google Scholar] [CrossRef]
- Qiu, L.; Shen, R.; Wei, L.; Xu, S.; Xia, W.; Hou, Y.; Cui, J.; Qu, R.; Luo, J.; Cao, J.; et al. Designing a microbial fermentation-functionalized alginate microsphere for targeted release of 5-ASA using nano dietary fiber carrier for inflammatory bowel disease treatment. J. Nanobiotechnol. 2023, 21, 344. [Google Scholar] [CrossRef]
- Chang, S.; Guo, Q.; Du, G.; Tang, J.; Liu, B.; Shao, K.; Zhao, X. Probiotic-loaded edible films made from proteins, polysaccharides, and prebiotics as a quality factor for minimally processed fruits and vegetables: A review. Int. J. Biol. Macromol. 2023, 253, 127226. [Google Scholar] [CrossRef] [PubMed]
- Sionek, B.; Szydłowska, A.; Zielińska, D.; Neffe-Skocińska, K.; Kołożyn-Krajewska, D. Beneficial Bacteria Isolated from Food in Relation to the Next Generation of Probiotics. Microorganisms 2023, 11, 1714. [Google Scholar] [CrossRef] [PubMed]
- Lee, S.; Kirkland, R.; Grunewald, Z.I.; Sun, Q.; Wicker, L.; de La Serre, C.B. Beneficial Effects of Non-Encapsulated or Encapsulated Probiotic Supplementation on Microbiota Composition, Intestinal Barrier Functions, Inflammatory Profiles, and Glucose Tolerance in High Fat Fed Rats. Nutrients 2019, 11, 1975. [Google Scholar] [CrossRef] [PubMed]
- Ma, Y.; Gou, S.; Zhu, Z.; Sun, J.; Shahbazi, M.A.; Si, T.; Xu, C.; Ru, J.; Shi, X.; Reis, R.L.; et al. Transient Mild Photothermia Improves Therapeutic Performance of Oral Nanomedicines with Enhanced Accumulation in the Colitis Mucosa. Adv. Mater. 2023, 36, e2309516. [Google Scholar] [CrossRef] [PubMed]
- Li, J.; Sun, M.; Liu, L.; Yang, W.; Sun, A.; Yu, J.; Dongchun, L.; Wutong, Z.; Maosheng, C.; Zhonggui, H.; et al. Nanoprobiotics for Remolding the Pro-inflammatory Microenvironment and Microbiome in the Treatment of Colitis. Nano Lett. 2023, 23, 8593–8601. [Google Scholar] [CrossRef] [PubMed]
- Cao, F.; Jin, L.; Gao, Y.; Ding, Y.; Wen, H.; Qian, Z.; Hong, L.; Yang, H.; Zhang, J.; Tong, Z.; et al. Artificial-enzymes-armed Bifidobacterium longum probiotics for alleviating intestinal inflammation and microbiota dysbiosis. Nat. Nanotechnol. 2023, 18, 617–627. [Google Scholar] [CrossRef]
- Chen, F.; Yang, C.; Shi, T.; Zhang, Y.; Chen, F.; Yang, C.; Guo, X.; Liu, G.; Shao, D.; Kam, W.; et al. Probiotic-Inspired Nanomedicine Restores Intestinal Homeostasis in Colitis by Regulating Redox Balance, Immune Responses, and the Gut Microbiome. Adv. Mater. 2023, 35, 2207890. [Google Scholar] [CrossRef] [PubMed]
- De Carvalho, A.P.A.; Conte-Junior, C.A. Food-derived biopolymer kefiran composites, nanocomposites and nanofibers: Emerging alternatives to food packaging and potentials in nanomedicine. Trends Food Sci. Technol. 2021, 116, 370–386. [Google Scholar] [CrossRef]
- Dangi, P.; Chaudhary, N.; Chaudhary, V.; Virdi, A.S.; Kajla, P.; Khanna, P.; Jha, S.K.; Jha, N.K.; Alkhanani, M.F.; Singh, V.; et al. Nanotechnology impacting probiotics and prebiotics: A paradigm shift in nutraceuticals technology. Int. J. Food Microbiol. 2023, 388, 110083. [Google Scholar] [CrossRef] [PubMed]
- Gurunathan, S.; Thangaraj, P.; Kim, J.H. Postbiotics: Functional Food Materials and Therapeutic Agents for Cancer, Diabetes, and Inflammatory Diseases. Foods 2023, 13, 89. [Google Scholar] [CrossRef] [PubMed]
- Heidarpour, F.; Mohammadabadi, M.R.; Zaidul, I.S.M.; Maherani, B.; Saari, N.; Hamid, A.A.; Manap, M.Y.A.; Mozafari, M.R. Use of prebiotics in oral delivery of bioactive compounds: A nanotechnology perspective. Die Pharm.-Int. J. Pharm. Sci. 2011, 66, 319–324. [Google Scholar] [CrossRef]
- Gu, Z.; Meng, S.; Wang, Y.; Lyu, B.; Li, P.; Shang, N. A novel bioactive postbiotics: From microbiota-derived extracellular nanoparticles to health promoting. Crit. Rev. Food Sci. Nutr. 2023, 63, 6885–6899. [Google Scholar] [CrossRef]
- Ozma, M.A.; Moaddab, S.R.; Hosseini, H.; Khodadadi, E.; Ghotaslou, R.; Asgharzadeh, M.; Abbasi, A.; Kamounah, F.S.; Maleki, L.A.; Ganbarov, K.; et al. A critical review of novel antibiotic resistance prevention approaches with a focus on postbiotics. Crit. Rev. Food Sci. Nutr. 2023, 1–19. [Google Scholar] [CrossRef]
- Azami, S.; Arefian, E.; Kashef, N. Postbiotics of Lactobacillus casei target virulence and biofilm formation of Pseudomonas aeruginosa by modulating quorum sensing. Arch. Microbiol. 2022, 204, 157. [Google Scholar] [CrossRef]
- Zafar, F.; Jahan, N.; Ali, S.; Jamil, S.; Hussain, R.; Aslam, S. Enhancing pharmaceutical potential and oral bioavailability of Allium cepa nanosuspension in male albino rats using response surface methodology. Asian Pac. J. Trop. Biomed. 2022, 12, 26–38. [Google Scholar] [CrossRef]
- Zafar, F.; Jahan, N.; Rahman, K.U.; Asi, M.R.; Zafar, W.U.I. Nanosuspension enhances dissolution rate and oral bioavailability of Terminalia arjuna bark extract in vivo and in vitro. Asian Pac. J. Trop. Biomed. 2020, 10, 164–171. [Google Scholar] [CrossRef]
- Erdogar, N.; Akkin, S.; Bilensoy, E. Nanocapsules for drug delivery: An updated review of the lastdecade. Recent Pat. Drug Deliv. Formul. 2018, 12, 252–266. [Google Scholar] [CrossRef]
- Madhuri, K. A review on the functions, preparation and future aspects of nanocapsules. Int. J. Sci. Res. Arch. 2023, 08, 421–426. [Google Scholar] [CrossRef]
- Das, D.; Maity, N.; Anuradha, H.V. Nanotechnology: A revolution in targeted drug delivery. Int. J. Basic Clin. Pharmacol. 2017, 6, 2766–2773. [Google Scholar] [CrossRef]
- Procopio, A.; Lagreca, E.; Jamaledin, R.; La Manna, S.; Corrado, B.; Di Natale, C.; Onesto, V. Recent Fabrication Methods to Produce Polymer-Based Drug Delivery Matrices (Experimental and In Silico Approaches). Pharmaceutics 2022, 14, 872. [Google Scholar] [CrossRef] [PubMed]
- Deng, S.; Gigliobianco, M.R.; Censi, R.; Di Martino, P. Polymeric Nanocapsules as Nanotechnological Alternative for Drug Delivery System: Current Status, Challenges and Opportunities. Nanomaterials 2020, 10, 847. [Google Scholar] [CrossRef] [PubMed]
- Hasheminejad, N.; Khodaiyan, F.; Safari, M. Improving the antifungal activity of clove essential oil encapsulated by chitosan nanoparticules. Food Chem. 2019, 275, 113–122. [Google Scholar] [CrossRef] [PubMed]
- Bussio, J.I.; Molina-Perea, C.; González-Aramundiz, J.V. Lower-Sized Chitosan Nanocapsules for Transcutaneous Antigen Delivery. Nanomaterials 2018, 8, 659. [Google Scholar] [CrossRef] [PubMed]
- Elbaz, N.M.; Owen, A.; Rannard, S.; McDonald, T.O. Controlled synthesis of calcium carbonate nanoparticles and stimuli-responsive multi-layered nanocapsules for oral drug delivery. Int. J. Pharm. 2020, 574, 118866. [Google Scholar] [CrossRef] [PubMed]
- Menard, M.; Meyer, F.; Parkhomenko, K.; Leuvrey, C.; Francius, G.; Begin-Colin, S.; Mertz, D. Mesoporous silica templated-albumin nanoparticles with high doxorubicin payload for drug delivery assessed with a 3-D tumor cell model. Biochim. Biophys. Acta Gen. Subj. 2019, 1863, 332–341. [Google Scholar] [CrossRef] [PubMed]
- Shang, B.; Zhang, X.; Ji, R.; Wang, Y.; Hu, H.; Peng, B.; Deng, Z. Preparation of colloidal polydopamine/Au hollow spheres for enhanced ultrasound contrast imaging and photothermal therapy. Mater. Sci. Eng. C 2020, 106, 110174. [Google Scholar] [CrossRef] [PubMed]
- Rata, D.M.; Cadinoiu, A.N.; Atanase, L.I.; Bacaita, S.E.; Mihalache, C.; Daraba, O.M.; Gherghel, D.; Popa, M. “In vitro ” behaviour of aptamer-functionalized polymeric nanocapsules loaded with 5-fluorouracil for targeted therapy. Mater. Sci. Eng. C 2019, 103, 109828. [Google Scholar] [CrossRef] [PubMed]
- Jafari, S.M. (Ed.) An overview of nanoencapsulation techniques and their classification. In Nanoencapsulation Technologies for the Food and Nutraceutical Industries; Academic Press: London, UK, 2017; pp. 1–34. [Google Scholar] [CrossRef]
- Human, C.; de Beer, D.; van der Rijst, M.; Aucamp, M.; Joubert, E. Electrospraying as a suitable method for nanoencapsulation of the hydrophilic bioactive dihydrochalcone, aspalathin. Food Chem. 2019, 276, 467–474. [Google Scholar] [CrossRef] [PubMed]
- Habib, S.; Singh, M. Recent Advances in Lipid-Based Nanosystems for Gemcitabine and Gemcitabine–Combination Therapy. Nanomaterials 2021, 11, 597. [Google Scholar] [CrossRef] [PubMed]
- Rodrigues, V.M.; Oliveira, W.N.; Pereira, D.T.; Alencar, É.N.; Porto, D.L.; Aragão, C.F.S.; Moreira, S.M.G.; Rocha, H.A.O.; Amaral-Machado, L.; Egito, E.S.T. Copaiba Oil-Loaded Polymeric Nanocapsules: Production and In Vitro Biosafety Evaluation on Lung Cells as a Pre-Formulation Step to Produce Phytotherapeutic Medicine. Pharmaceutics 2023, 15, 161. [Google Scholar] [CrossRef] [PubMed]
- Oliveira, A.C.S.; Oliveira, P.M.; Cunha-Filho, M.; Gratieri, T.; Gelfuso, G.M. Latanoprost loaded in polymeric nanocapsules for effective topical treatment of alopecia. AAPS PharmSciTech 2020, 21, 305. [Google Scholar] [CrossRef] [PubMed]
- Mora-Huertas, C.E.; Fessi, H.; Elaissari, A. Polymer-based drug-delivery nanocapsules. Int. J. Pharm. 2010, 385, 113–142. [Google Scholar] [CrossRef] [PubMed]
- Kothamasu, P.; Kanumur, H.; Ravur, N.; Maddu, C.; Parasuramrajam, R.; Thangavel, S. Nanocapsules: The weapons for novel drug delivery systems. Bioimpacts BI 2012, 2, 71–81. [Google Scholar] [CrossRef] [PubMed]
- Shastri, V.P. Non-degradable biocompatible polymers in medicine: Past, present and future. Curr. Pharm. Biotechnol. 2003, 4, 331–337. [Google Scholar] [CrossRef] [PubMed]
- Almeida, J.P.M.; Chen, A.L.; Foster, A.; Drezek, R.J.N. In vivo biodistribution of nanoparticles. Nanomedicine 2011, 6, 815–835. [Google Scholar] [CrossRef] [PubMed]
- Ventola, C.L. Medical Applications for 3D Printing: Current and Projected Uses. Pharm. Ther. 2014, 39, 704–711. [Google Scholar] [PubMed Central]
- Goyanes, A.; Robles-Martinez, P.; Buanz, A.B.M.; Basit, A.W.; Gaisford, S. Effect of Geometry on Drug Release from 3D Printed Tablets. Int. J. Pharm. 2015, 494, 657–663. [Google Scholar] [CrossRef]
- Lim, S.H.; Kathuria, H.; Tan, J.J.Y. 3D Printing of Polymers for Biomedical Applications. Eur. Polym. J. 2020, 133, 109812. [Google Scholar] [CrossRef]
- Wang, H.; Zhou, L.; Liao, J.; Tan, W.; Liu, J.; Lin, H.; Liao, L. 3D Printing of Conductive Nanomaterials for Flexible Electronics and Energy Applications: A Review. Nanoscale 2019, 11, 19279–19304. [Google Scholar] [CrossRef]
- Zhang, B.; Li, S.; Hingorani, H.; Serjouei, A.; Larush, L.; Pawar, A.A.; Goh, W.H.; Sakhaei, A.H.; Hashimoto, M.; Kowsari, K.; et al. Highly stretchable hydrogels for UV curing based high-resolution multimaterial 3D printing. J. Mater. Chem. B. 2018, 6, 3246–3253. [Google Scholar] [CrossRef] [PubMed]
- Choudhury, A.; Das, S.; Bahadur, S.; Saha, S.; Roy, A. Formulation and Evaluation of 3D Printed Omeprazole Tablets. Indian J. Pharm. Sci. 2010, 72, 491–494. [Google Scholar] [CrossRef] [PubMed]
- Cardoso, P.H.; Araújo, E.S. An Approach to 3D Printing Techniques, Polymer Materials, and Their Applications in the Production of Drug Delivery Systems. Compounds 2024, 4, 71–105. [Google Scholar] [CrossRef]
- Yu, L.X. Pharmaceutical quality by design: Product and process development, understanding, and control. Pharm. Res. 2008, 25, 781–791. [Google Scholar] [CrossRef] [PubMed]
- Martinez-Marquez, D.; Mirnajafizadeh, A.; Carty, C.P.; Stewart, R.A. Application of quality by design for 3D printed bone prostheses and scaffolds. PLoS ONE 2018, 13, e0195291. [Google Scholar] [CrossRef] [PubMed]
- Thanawuth, K.; Sutthapitaksakul, L.; Konthong, S.; Suttiruengwong, S.; Huanbutta, K.; Dass, C.R.; Sriamornsak, P. Impact of Drug Loading Method on Drug Release from 3D-Printed Tablets Made from Filaments Fabricated by Hot-Melt Extrusion and Impregnation Processes. Pharmaceutics 2021, 13, 1607. [Google Scholar] [CrossRef] [PubMed]
- Gross, B.C.; Erkal, J.L.; Lockwood, S.Y.; Chen, C.; Spence, D.M. Evaluation of 3D printing and its potential impact on biotechnology and the chemical sciences. Anal Chem. 2014, 86, 3240–3253. [Google Scholar] [CrossRef] [PubMed]
- Prasad, L.K.; Smyth, H. 3D Printing technologies for drug delivery: A review. Drug Dev. Ind. Pharm. 2015, 42, 1019–1031. [Google Scholar] [CrossRef] [PubMed]
- Zhu, Y.; Tang, T.; Zhao, S.; Joralmon, D.; Poit, Z.; Ahire, B.; Keshav, S.; Raje, A.R.; Blair, J.; Zhang, Z.; et al. Recent advancements and applications in 3D printing of functional optics. Addit. Manuf. 2022, 52, 102682. [Google Scholar] [CrossRef]
- Borandeh, S.; Van Bochove, B.; Teotia, A.; Seppälä, J. Polymeric drug delivery systems by additive manufacturing. Adv. Drug Deliv. Rev. 2021, 173, 349–373. [Google Scholar] [CrossRef]
- Ochubiojo, M.; Chinwude, I.; Ibanga, E.; Ifianyi, S. Nanotechnology in Drug Delivery. In Recent Advances in Novel Drug Carrier Systems; IntechOpen Limited: London, UK, 2012. [Google Scholar] [CrossRef]
- Goyanes, A.; Det-Amornrat, U.; Wang, J.; Basit, A.W.; Gaisford, S. 3D Scanning and 3D Printing as Innovative Technologies for Fabricating Personalised Topical Drug Delivery Systems. J. Control. Release 2016, 234, 41–48. [Google Scholar] [CrossRef] [PubMed]
- Jacob, S.; Nair, A.B.; Patel, V.; Shah, J.N. 3D Printing Technologies: Recent Development and Emerging Applications in Various Drug Delivery Systems. AAPS PharmSciTech 2020, 21, 220. [Google Scholar] [CrossRef] [PubMed]
- Ma, Y.; Deng, B.; He, R.; Huang, P. Advancements of 3D bioprinting in regenerative medicine: Exploring cell sources for organ fabrication. Heliyon 2024, 10, e24593. [Google Scholar] [CrossRef]
- Zhang, Y.S.; Yue, K.; Aleman, J.; Mollazadeh-Moghaddam, K.; Bakht, S.M.; Yang, J.; Khademhosseini, A. 3D Bioprinting for Tissue and Organ Fabrication. Ann. Biomed. Eng. 2017, 45, 148–163. [Google Scholar] [CrossRef]
- Malda, J.; Visser, J.; Melchels, F.P.W.; Jüngst, T.; Hennink, W.E.; Dhert, W.J.A.; Hutmacher, D.W. 25th Anniversary Article: Engineering Hydrogels for Biofabrication. Adv. Mater. 2013, 25, 5011–5028. [Google Scholar] [CrossRef] [PubMed]
- Ozbolat, I.T.; Hospodiuk, M. Current Advances and Future Perspectives in Extrusion-Based Bioprinting. Biomaterials 2016, 76, 321–343. [Google Scholar] [CrossRef] [PubMed]
- Lee, W.; Debasitis, J.C.; Lee, V.K.; Lee, J.H.; Fischer, K.; Edminster, K.; Yoo, S.-S. Multi-Layered Culture of Human Skin Fibroblasts and Keratinocytes through Three-Dimensional Freeform Fabrication. Biomaterials 2009, 30, 1587–1595. [Google Scholar] [CrossRef]
- Chimene, D.; Lennox, K.K.; Kaunas, R.R.; Gaharwar, A.K. Advanced Bioinks for 3D Printing: A Materials Science Perspective. Ann. Biomed. Eng. 2016, 44, 2090–2102. [Google Scholar] [CrossRef] [PubMed]
- Mannoor, M.S.; Jiang, Z.; James, T.; Kong, Y.L.; Malatesta, K.A.; Soboyejo, W.O.; McAlpine, M.C. 3D Printed Bionic Ears. Nano Lett. 2013, 13, 2634–2639. [Google Scholar] [CrossRef] [PubMed]
- Bishop, E.S.; Mostafa, S.; Pakvasa, M.; Luu, H.H.; Lee, M.J.; Wolf, J.M.; Davis, T.A. 3-D Bioprinting Technologies in Tissue Engineering and Regenerative Medicine: Current and Future Trends. Genes Dis. 2017, 4, 185–195. [Google Scholar] [CrossRef] [PubMed]
- Lin, H.; Zhang, D.; Alexander, P.G.; Yang, G.; Tan, J.; Cheng, A.W.-M.; Tuan, R.S. Application of Visible Light-Based Projection Stereolithography for Live Cell-Scaffold Fabrication with Designed Architecture. Biomaterials 2016, 34, 331–339. [Google Scholar] [CrossRef] [PubMed]
- Tasoglu, S.; Demirci, U.; Demirci, U. Bioprinting for Stem Cell Research. Trends Biotechnol. 2013, 31, 10–19. [Google Scholar] [CrossRef] [PubMed]
- Mandrycky, C.; Wang, Z.; Kim, K.; Kim, D.-H. 3D Bioprinting for Engineering Complex Tissues. Biotechnol. Adv. 2016, 34, 422–434. [Google Scholar] [CrossRef] [PubMed]
- Murphy, S.V.; Atala, A. 3D Bioprinting of Tissues and Organs. Nat. Biotechnol. 2014, 32, 773–785. [Google Scholar] [CrossRef] [PubMed]
- Bajaj, P.; Schweller, R.M.; Khademhosseini, A.; West, J.L. Bashir, 3D Biofabrication Strategies for Tissue Engineering and Regenerative Medicine. Annu. Rev. Biomed. Eng. 2014, 16, 247–276. [Google Scholar] [CrossRef]
- Gungor-Ozkerim, P.S.; Inci, I.; Zhang, Y.S.; Khademhosseini, A.; Dokmeci, M.R. Bioinks for 3D Bioprinting: An Overview. Biomater. Sci. 2018, 6, 915–946. [Google Scholar] [CrossRef] [PubMed]
- Ventola, C.L. Progress in 3D Printing: Medicine. PT A Peer-Rev. J. Formul. Manag. 2017, 42, 298–308. [Google Scholar]
- Goyanes, A.; Wang, J.; Buanz, A.; Martínez-Pacheco, R.; Telford, R.; Gaisford, S.; Basit, A.W. 3D Printing of Medicines: Engineering Novel Oral Devices with Unique Design and Drug Release Characteristics. Mol. Pharm. 2015, 12, 4077–4084. [Google Scholar] [CrossRef] [PubMed]
- Gazzaniga, A.; Foppoli, A.; Cerea, M.; Palugan, L.; Cirilli, M.; Moutaharrik, S.; Melocchi, A.; Maroni, A. Towards 4D printing in pharmaceutics. Int. J. Pharm. X 2023, 5, 100171. [Google Scholar] [CrossRef] [PubMed]
- Patel, D.K.; Sakhaei, A.H.; Layani, M.; Zhang, B.; Ge, Q.; Magdassi, S. Highly Stretchable and UV Curable Elastomers for Digital Light Processing Based 3D Printing. Adv. Mater. 2017, 29, 1606000. [Google Scholar] [CrossRef] [PubMed]
- Wu, W.; Liu, X.; Zhou, Z.; Miller, A.L.; Lu, L. Three-dimensional porous poly(propylene fumarate)-co-poly(lactic-co-glycolic acid) scaffolds for tissue engineering. J. Biomed. Mater. Res. A 2018, 106, 2507–2517. [Google Scholar] [CrossRef] [PubMed]
- Serrano, D.R.; Kara, A.; Yuste, I.; Luciano, F.C.; Ongoren, B.; Anaya, B.J.; Molina, G.; Diez, L.; Ramirez, B.I.; Ramirez, I.O.; et al. 3D Printing Technologies in Personalized Medicine, Nanomedicines, and Biopharmaceuticals. Pharmaceutics 2023, 15, 313. [Google Scholar] [CrossRef] [PubMed]
- Algahtani, M.S.; Mohammed, A.A.; Ahmad, J.; Abdullah, M.M.; Saleh, E. 3D Printing of Dapagliflozin Containing Self-Nanoemulsifying Tablets: Formulation Design and In Vitro Characterization. Pharmaceutics 2021, 13, 993. [Google Scholar] [CrossRef] [PubMed]
- Shi, J.; Kantoff, P.W.; Wooster, R.; Farokhzad, O.C. Cancer nanomedicine: Progress, challenges and opportunities. Nat. Rev. Cancer 2017, 17, 20–37. [Google Scholar] [CrossRef] [PubMed]
- Kim, K.Y. Nanotechnology platforms and physiological challenges for cancer therapeutics. Nanomedicine 2007, 3, 103–110. [Google Scholar] [CrossRef] [PubMed]
- Blanco, E.; Shen, H.; Ferrari, M. Principles of nanoparticle design for overcoming biological barriers to drug delivery. Nat. Biotechnol. 2015, 33, 941–951. [Google Scholar] [CrossRef]
- Langer, R.; Tirrell, D.A. Designing materials for biology and medicine. Nature 2004, 428, 487–492. [Google Scholar] [CrossRef] [PubMed]
- Torchilin, V.P. Recent advances with liposomes as pharmaceutical carriers. Nat. Rev. Drug Discov. 2006, 4, 145–160. [Google Scholar] [CrossRef] [PubMed]
- Farokhzad, O.C.; Langer, R. Impact of nanotechnology on drug delivery. ACS Nano 2009, 3, 16–20. [Google Scholar] [CrossRef] [PubMed]
- Hrkach, J.; Von Hoff, D.; Ali, M.M.; Andrianova, E.; Auer, J.; Campbell, T.; Zalipsky, S. Preclinical development and clinical translation of a PSMA-targeted docetaxel nanoparticle with a differentiated pharmacological profile. Sci. Transl. Med. 2012, 4, 128ra39. [Google Scholar] [CrossRef] [PubMed]
- Jain, R.K.; Stylianopoulos, T.; Munn, L.L. The role of mechanical forces in tumor growth and therapy. Annu. Rev. Biomed. Eng. 2014, 16, 321–346. [Google Scholar] [CrossRef] [PubMed]
- Allen, T.M.; Cullis, P.R. Liposomal drug delivery systems: From concept to clinical applications. Adv. Drug Deliv. Rev. 2013, 65, 36–48. [Google Scholar] [CrossRef] [PubMed]
- Cabral, H.; Kataoka, K. Progress of drug-loaded polymeric micelles into clinical studies. J. Control. Release 2014, 190, 465–476. [Google Scholar] [CrossRef] [PubMed]
- Jokerst, J.V.; Lobovkina, T.; Zare, R.N.; Gambhir, S.S. Nanoparticle PEGylation for imaging and therapy. Nanomedicine 2011, 6, 715–728. [Google Scholar] [CrossRef] [PubMed]
- Wilhelm, S.; Tavares, A.J.; Dai, Q.; Ohta, S.; Audet, J.; Dvorak, H.F.; Chan, W.C. Analysis of nanoparticle delivery to tumours. Nat. Rev. Mater. 2016, 1, 16014. [Google Scholar] [CrossRef]
- Fang, J.; Nakamura, H.; Maeda, H. The EPR effect: Unique features of tumor blood vessels for drug delivery, factors involved, and limitations and augmentation of the effect. Adv. Drug Deliv. Rev. 2011, 63, 136–151. [Google Scholar] [CrossRef] [PubMed]
- Leach, D.G.; Young, S.; Hartgerink, J.D. Advances in immunotherapy delivery from implantable and injectable biomaterials. Acta Biomater. 2019, 88, 15–31. [Google Scholar] [CrossRef]
- Bertrand, N.; Wu, J.; Xu, X.; Kamaly, N.; Farokhzad, O.C. Cancer nanotechnology: The impact of passive and active targeting in the era of modern cancer biology. Adv. Drug Deliv. Rev. 2014, 66, 2–25. [Google Scholar] [CrossRef] [PubMed]
- Bae, Y.H.; Park, K. Targeted drug delivery to tumors: Myths, reality and possibility. J. Control. Release 2011, 153, 198–205. [Google Scholar] [CrossRef] [PubMed]
- Jokerst, J.V.; Gambhir, S.S.; Liu, A. Molecular imaging with theranostic nanoparticles. Acc. Chem. Res. 2011, 44, 1050–1060. [Google Scholar] [CrossRef] [PubMed]
- Swierczewska, M.; Han, H.S.; Kim, K.; Park, J.H.; Lee, S. Polysaccharide-based nanoparticles for theranostic nanomedicine. Adv. Drug Deliv. Rev. 2016, 99, 70–84. [Google Scholar] [CrossRef] [PubMed]
- Caravan, P.; Ellison, J.J.; McMurry, T.J.; Lauffer, R.B. Gadolinium (III) chelates as MRI contrast agents: Structure, dynamics, and applications. Chem. Rev. 1999, 99, 2293–2352. [Google Scholar] [CrossRef] [PubMed]
- Sumer, B.; Gao, J. Theranostic nanomedicine for cancer. Nanomedicine 2008, 3, 137–140. [Google Scholar] [CrossRef] [PubMed]
- Kučuk, N.; Primožič, M.; Knez, E.; Leitgeb, M. Exosomes Engineering and Their Roles as Therapy Delivery Tools, Therapeutic Targets, and Biomarkers. Int. J. Mol. Sci. 2021, 22, 9543. [Google Scholar] [CrossRef] [PubMed]
- Bobo, D.; Robinson, K.J.; Islam, J.; Thurecht, K.J.; Corrie, S.R. Nanoparticle-based medicines: A review of FDA-approved materials and clinical trials to date. Pharm. Res. 2016, 33, 2373–2387. [Google Scholar] [CrossRef] [PubMed]
- Prabhakar, U.; Maeda, H.; Jain, R.K.; Sevick-Muraca, E.M.; Zamboni, W.; Farokhzad, O.C.; Blakey, D.C. Challenges and key considerations of the enhanced permeability and retention effect for nanomedicine drug delivery in oncology. Cancer Res. 2013, 73, 2412–2417. [Google Scholar] [CrossRef] [PubMed]
- Xu, M.; Han, X.; Xiong, H.; Gao, Y.; Xu, B.; Zhu, G.; Li, J. Cancer Nanomedicine: Emerging Strategies and Therapeutic Potentials. Molecules 2023, 28, 5145. [Google Scholar] [CrossRef] [PubMed]
- Hillaireau, H.; Couvreur, P. Nanocarriers’ entry into the cell: Relevance to drug delivery. Cell. Mol. Life Sci. 2009, 66, 2873–2896. [Google Scholar] [CrossRef] [PubMed]
- Peer, D.; Karp, J.M.; Hong, S.; Farokhzad, O.C. Nanocarriers as an emerging platform for cancer therapy. Nat. Nanotechnol. 2007, 2, 751–760. [Google Scholar] [CrossRef] [PubMed]
- He, H.; Liu, L.; Morin, E.E.; Liu, M.; Schwendeman, A. Survey of Clinical Translation of Cancer Nanomedicines-Lessons Learned from Successes and Failures. Acc. Chem. Res. 2019, 52, 2445–2461. [Google Scholar] [CrossRef] [PubMed]
- Singh, R.; Lillard, J.W., Jr.; Singh, S. Chemokines: Key players in cancer progression and metastasis. Front. Biosci. 2009, 14, 847–871. [Google Scholar] [CrossRef] [PubMed][Green Version]
- Torchilin, V.P. Multifunctional, stimuli-sensitive nanoparticulate systems for drug delivery. Nat. Rev. Drug Discov. 2014, 13, 813–827. [Google Scholar] [CrossRef] [PubMed]
- Koo, O.M.; Rubinstein, I.; Onyuksel, H. Role of nanotechnology in targeted drug delivery and imaging: A concise review. Nanomed. Nanotechnol. Biol. Med. 2005, 1, 193–212. [Google Scholar] [CrossRef] [PubMed]
- Binaymotlagh, R.; Hajareh, H.F.; Chronopoulou, L.; Palocci, C. Liposome-Hydrogel Composites for Controlled Drug Delivery Applications. Gels 2024, 10, 284. [Google Scholar] [CrossRef] [PubMed]
- Shi, J.; Kantoff, P.W. Advances in biomaterials for cancer immunotherapy. Biomaterials 2017, 65, 1–15. [Google Scholar] [CrossRef] [PubMed]
- Yan, S.; Na, J.; Liu, X.; Wu, P. Different Targeting Ligands-Mediated Drug Delivery Systems for Tumor Therapy. Pharmaceutics 2024, 16, 248. [Google Scholar] [CrossRef]
- Maeda, H. The enhanced permeability and retention (EPR) effect in tumor vasculature: The key role of tumor-selective macromolecular drug targeting. Adv. Enzym. Regul. 2001, 41, 189–207. [Google Scholar] [CrossRef] [PubMed]
- Davis, M.E. The first targeted delivery of siRNA in humans via a nanoparticle-based therapeutic. Mol. Pharm. 2009, 6, 659–668. [Google Scholar] [CrossRef] [PubMed]
- Moghimi, S.M.; Farhangrazi, Z.S. Just so stories: The random acts of anti-cancer nanomedicine performance. Nanomed. Nanotechnol. Biol. Med. 1998, 5, 107–110. [Google Scholar] [CrossRef] [PubMed]
- Wolinsky, J.B.; Grinstaff, M.W. Therapeutic and diagnostic applications of dendrimers for cancer treatment. Adv. Drug Deliv. Rev. 2008, 60, 1037–1055. [Google Scholar] [CrossRef] [PubMed]
- Soprano, E.; Polo, E.; Pelaz, B.; Del Pino, P. Biomimetic cell-derived nanocarriers in cancer research. J. Nanobiotechnol. 2022, 20, 538. [Google Scholar] [CrossRef]
- Sengupta, S.; Eavarone, D.; Capila, I.; Zhao, G.; Watson, N.; Kiziltepe, T.; Sasisekharan, R. Temporal targeting of tumour cells and neovasculature with a nanoscale delivery system. Nature 2005, 436, 568–572. [Google Scholar] [CrossRef]
- Nel, A.E.; Mädler, L.; Velegol, D.; Xia, T.; Hoek, E.M.; Somasundaran, P.; Thompson, M. Understanding biophysicochemical interactions at the nano–bio interface. Nat. Mater. 2009, 8, 543–557. [Google Scholar] [CrossRef] [PubMed]
- Dreaden, E.C.; Alkilany, A.M.; Huang, X.; Murphy, C.J.; El-Sayed, M.A. The golden age: Gold nanoparticles for biomedicine. Chem. Soc. Rev. 2012, 41, 2740–2779. [Google Scholar] [CrossRef] [PubMed]
- Riehemann, K.; Schneider, S.W.; Luger, T.A.; Godin, B.; Ferrari, M.; Fuchs, H. Nanomedicine—Challenge and perspectives. Angew. Chem. Int. Ed. 2009, 48, 872–897. [Google Scholar] [CrossRef]
- Gao, X.; Cui, Y.; Levenson, R.M.; Chung, L.W.; Nie, S. In vivo cancer targeting and imaging with semiconductor quantum dots. Nat. Biotechnol. 2004, 22, 969–976. [Google Scholar] [CrossRef] [PubMed]
- De Jong, W.H.; Borm, P.J. Drug delivery and nanoparticles: Applications and hazards. Int. J. Nanomed. 2008, 3, 133–149. [Google Scholar] [CrossRef]
- Su, S.; Kang, P.M. Recent Advances in Nanocarrier-Assisted Therapeutics Delivery Systems. Pharmaceutics 2020, 12, 837. [Google Scholar] [CrossRef]
- Jain, K.K. Nanotechnology-based Drug Delivery for Cancer. Technol. Cancer Res. Treat. 2005, 4, 407–416. [Google Scholar] [CrossRef] [PubMed]
- Li, J.; Feng, L.; Fan, L.; Zha, Y.; Guo, L.; Zhang, Q.; Song, Q. Targeting the brain with PEG–PLGA nanoparticles modified with phage-displayed peptides. Biomater. Sci. 2016, 4, 501–509. [Google Scholar] [CrossRef] [PubMed]
- Li, J.; Yu, F.; Chen, Y.; Oupický, D.; Sun, M. Self-assembled supramolecular nano vesicles for safe and highly efficient gene delivery to solid tumors. Int. J. Pharm. 2017, 524, 394–403. [Google Scholar] [CrossRef] [PubMed]
- Chen, S.; Zhong, H.; Gu, B.; Wang, Y.; Li, X.; Cheng, Z.; Zhang, L.; Yao, C. Thermosensitive phase behavior and drug release of in situ N-isopropylacrylamide copolymer. Mater. Sci. Eng. C 2012, 32, 2199–2204. [Google Scholar] [CrossRef]
- Long, H.; Tian, W.; Jiang, S.; Zhao, J.; Zhou, J.; He, Q.; Tang, Z.; Shen, W.; Wang, J. A dual drug delivery platform based on thermo-responsive polymeric micelle capped mesoporous silica nanoparticles for cancer therapy. Microporous Mesoporous Mater. 2022, 338, 111943. [Google Scholar] [CrossRef]
- Zhou, W.; Jia, Y.; Liu, Y.; Chen, Y.; Zhao, P. Tumor Microenvironment-Based Stimuli-Responsive Nanoparticles for Controlled Release of Drugs in Cancer Therapy. Pharmaceutics 2022, 14, 2346. [Google Scholar] [CrossRef] [PubMed]
- Lin, G.-Q.; Yi, W.-J.; Liu, Q.; Yang, X.-J.; Zhao, Z.-G. Aromatic Thioacetal-Bridged ROS-Responsive Nanoparticles as Novel Gene Delivery Vehicles. Molecules 2018, 23, 2061. [Google Scholar] [CrossRef] [PubMed]
- Xie, W.; Zhang, S.; Pan, F.; Chen, S.; Zhong, L.; Wang, J.; Pei, X. Nanomaterial-based ROS-mediated strategies for combating bacteria and biofilms. J. Mater. Res. 2021, 36, 822–845. [Google Scholar] [CrossRef]
- Ghazal, H.; Waqar, A.; Yaseen, F.; Shahid, M.; Sultana, M.; Tariq, M.; Bashir, M.K.; Tahseen, H.; Raza, T.; Ahmad, F. Role of nanoparticles in enhancing chemotherapy efficacy for cancer treatment. Next Mater. 2024, 2, 100128. [Google Scholar] [CrossRef]
- Gupta, D.; Roy, P.; Sharma, R.; Kasana, R.; Rathore, P.; Gupta, T.K. Recent nanotheranostic approaches in cancer research. Clin. Exp. Med. 2024, 24, 8. [Google Scholar] [CrossRef] [PubMed]
- Park, K. Facing the truth about nanotechnology in drug delivery. ACS Nano 2016, 10, 8453–8456. [Google Scholar] [CrossRef] [PubMed]
- Cheng, R.; Meng, F.; Deng, C.; Klok, H.A.; Zhong, Z. Dual and multi-stimuli responsive polymeric nanoparticles for programmed site-specific drug delivery. Biomaterials 2013, 34, 3647–3657. [Google Scholar] [CrossRef] [PubMed]
- Sun, W.; Ji, W.; Hall, J.M.; Hu, Q.; Wang, C.; Beisel, C.L.; Gu, Z. Self-assembled DNA nanoclews for the efficient delivery of CRISPR–Cas9 for genome editing. Angew. Chem. Int. Ed. 2017, 56, 11927–11931. [Google Scholar] [CrossRef] [PubMed]
- Lu, Y.; Aimetti, A.A.; Langer, R.; Gu, Z. Bioresponsive materials. Nat. Rev. Mater. 2016, 2, 16075. [Google Scholar] [CrossRef]
- Lee, S.M.; Lee, E.J.; Hong, H.Y.; Kwon, M.K.; Kwon, T.H.; Choi, J.Y.; Park, R.W. Targeting bladder tumor cells in vivo and in the urine with a peptide identified by phage display. Mol. Cancer Res. 2007, 5, 11–19. [Google Scholar] [CrossRef] [PubMed]
- Rosenblum, D.; Joshi, N.; Tao, W.; Karp, J.M.; Peer, D. Progress and challenges towards targeted delivery of cancer therapeutics. Nat. Commun. 2018, 9, 1410. [Google Scholar] [CrossRef] [PubMed]
- Parveen, S.; Gupta, P.; Kumar, S.; Banerjee, M. Lipid polymer hybrid nanoparticles as potent vehicles for drug delivery in cancer therapeutics. Med. Drug Discov. 2023, 20, 100165. [Google Scholar] [CrossRef]
- Liu, D.; Yang, F.; Xiong, F.; Gu, N. The smart drug delivery system and its clinical potential. Theranostics 2017, 7, 1306–1323. [Google Scholar] [CrossRef] [PubMed]
- Acharya, S.; Sahoo, S.K. PLGA nanoparticles containing various anticancer agents and tumour delivery by EPR effect. Adv. Drug Deliv. Rev. 2011, 63, 170–183. [Google Scholar] [CrossRef] [PubMed]
- Tao, W.; Zeng, X.; Wu, J.; Zhu, X.; Yu, X.; Zhang, X.; Zhang, J.; Liu, G.; Mei, L. Polydopamine-based surface modification of novel nanoparticle-aptamer bioconjugates for in vivo breast cancer targeting and enhanced therapeutic effects. Theranostics 2017, 7, 4116–4136. [Google Scholar] [CrossRef]
- Hua, S.; Wu, S.Y. The use of lipid-based nanocarriers for targeted pain therapies. Front. Pharmacol. 2013, 4, 143. [Google Scholar] [CrossRef] [PubMed]
- Puccetti, M.; Pariano, M.; Schoubben, A.; Giovagnoli, S.; Ricci, M. Biologics, theranostics, and personalized medicine in drug delivery systems. Pharmacol. Res. 2024, 201, 107086. [Google Scholar] [CrossRef] [PubMed]
- Wang, Z.; Qiao, R.; Tang, N.; Lu, Z.; Wang, H.; Zhang, Z.; Xue, X.; Huang, Z.; Zhang, S.; Zhang, G.; et al. Active targeting theranostic iron oxide nanoparticles for MRI and magnetic resonance-guided focused ultrasound ablation of lung cancer. Biomaterials 2017, 127, 25–35. [Google Scholar] [CrossRef] [PubMed]
- Moermond, C.T.A.; Puhlmann, N.; Brown, A.R.; Owen, S.F.; Ryan, J.; Snape, J.; Venhuis, B.J.; Kümmerer, K. GREENER Pharmaceuticals for More Sustainable Healthcare. Environ. Sci. Technol. Lett. 2022, 9, 699–705. [Google Scholar] [CrossRef] [PubMed]
- Kümmerer, K. From a problem to a business opportunity-design of pharmaceuticals for environmental biodegradability. Sustain. Chem. Pharm. 2019, 12, 100136. [Google Scholar] [CrossRef]
- Verma, A.; Gautam, S.P.; Bansal, K.K.; Prabhakar, N.; Rosenholm, J.M. Green Nanotechnology: Advancement in Phytoformulation Research. Medicines 2019, 6, 39. [Google Scholar] [CrossRef]
- Zahmanova, G.; Aljabali, A.A.A.; Takova, K.; Minkov, G.; Tambuwala, M.M.; Minkov, I.; Lomonossoff, G.P. Green Biologics: Harnessing the Power of Plants to Produce Pharmaceuticals. Int. J. Mol. Sci. 2023, 24, 17575. [Google Scholar] [CrossRef] [PubMed]
- Kanwar, R.; Rathee, J.; Salunke, D.B.; Mehta, S.K. Green Nanotechnology-Driven Drug Delivery Assemblies. ACS Omega 2019, 4, 8804–8815. [Google Scholar] [CrossRef] [PubMed]
- Kadkhoda, J.; Tarighatnia, A.; Barar, J.; Aghanejad, A.; Davaran, S. Recent advances and trends in nanoparticles based photothermal and photodynamic therapy. Photodiagnosis Photodyn. Ther. 2022, 37, 102697. [Google Scholar] [CrossRef] [PubMed]
- Wang, S.; Ma, R.; Zhang, H.; Li, L.; Li, X.; Zhao, Y.; Wang, L.; Mao, X. Construction of a high affinity aptamer and an aptasensor with chitosan oligosaccharide-AuNPs@Fe2+ nanozyme for highly sensitive detection of phosphatidylserine. Sens. Actuators B Chem. 2022, 362, 131800. [Google Scholar] [CrossRef]
- Rust, T.; Jung, D.; Hoppe, A.; Schoppa, T.; Langer, K.; Kuckling, D. Backbone-Degradable (Co-)Polymers for Light-Triggered Drug Delivery. ACS Appl. Polym. Mater. 2021, 3, 3831–3842. [Google Scholar] [CrossRef]
- Johnson, J.A.; Lu, Y.Y.; Burts, A.O.; Lim, Y.-H.; Finn, M.G.; Koberstein, J.T.; Turro, N.J.; Tirrell, D.A.; Grubbs, R.H. Core-clickable PEG-branch-azide bivalent-bottle-brush polymers by ROMP: Grafting-through and clicking-to. J. Am. Chem. Soc. 2011, 133, 559–566. [Google Scholar] [CrossRef] [PubMed]
- Liu, Y.; Bhattarai, P.; Dai, Z.; Chen, X. Photothermal therapy and photoacoustic imaging via nanotheranostics in fighting cancer. Chem. Soc. Rev. 2019, 48, 2053–2108. [Google Scholar] [CrossRef] [PubMed]
- Rodríguez, F.; Caruana, P.; De la Fuente, N.; Español, P.; Gámez, M.; Balart, J.; Llurba, E.; Rovira, R.; Ruiz, R.; Martín-Lorente, C.; et al. Nano-Based Approved Pharmaceuticals for Cancer Treatment: Present and Future Challenges. Biomolecules 2022, 12, 784. [Google Scholar] [CrossRef] [PubMed]
- Overchuk, M.; Weersink, R.A.; Wilson, B.C.; Zheng, G. Photodynamic and photothermal therapies: Synergy opportunities for nanomedicine. ACS Nano 2023, 17, 7979–8003. [Google Scholar] [CrossRef] [PubMed]
- Yoo, S.W.; Oh, G.; Ahn, J.C.; Chung, E. Non-Oncologic Applications of Nanomedicine-Based Phototherapy. Biomedicines 2021, 9, 113. [Google Scholar] [CrossRef]
- Gallo, J.; Villasante, A. Recent Advances in Biomimetic Nanocarrier-Based Photothermal Therapy for Cancer Treatment. Int. J. Mol. Sci. 2023, 24, 15484. [Google Scholar] [CrossRef]
- Tian, Y.; Carrillo-Malani, N.; Feng, K.; Miller, J.; Busch, T.M.; Sundaram, K.M.; Cheng, Z.; Amirshaghaghi, A.; Tsourkas, A. Theranostic Phthalocyanine and Naphthalocyanine Nanoparticles for Photoacoustic Imaging and Photothermal Therapy of Tumors. Nanotheranostics 2024, 8, 100–111. [Google Scholar] [CrossRef]
- Younis, M.R.; Wang, C.; An, R.; Wang, S.; Younis, M.A.; Li, Z.-Q.; Wang, Y.; Ihsan, A.; Ye, D.; Xia, X.-H. Low Power Single Laser Activated Synergistic Cancer Phototherapy Using Photosensitizer Functionalized Dual Plasmonic Photothermal Nanoagents. ACS Nano 2019, 13, 2544–2557. [Google Scholar] [CrossRef] [PubMed]
- Kumar, P.P.P.; Lim, D.-K. Photothermal Effect of Gold Nanoparticles as a Nanomedicine for Diagnosis and Therapeutics. Pharmaceutics 2023, 15, 2349. [Google Scholar] [CrossRef]
- Meeker, D.G.; Jenkins, S.V.; Miller, E.K.; Beenken, K.E.; Loughran, A.J.; Powless, A.; Chen, J. Synergistic Photothermal and Antibiotic Killing of Biofilm-Associated Staphylococcus aureus Using Targeted Antibiotic-Loaded Gold Nanoconstructs. ACS Infect. Dis. 2016, 2, 241–250. [Google Scholar] [CrossRef] [PubMed]
- Mokoena, D.; George, B.P.; Abrahamse, H. Conjugation of Hypericin to Gold Nanoparticles for Enhancement of Photodynamic Therapy in MCF-7 Breast Cancer Cells. Pharmaceutics 2022, 14, 2212. [Google Scholar] [CrossRef] [PubMed]
- Yougbaré, S.; Mutalik, C.; Chung, P.-F.; Krisnawati, D.I.; Rinawati, F.; Irawan, H.; Kristanto, H.; Kuo, T.-R. Gold Nanorod-Decorated Metallic MoS2 Nanosheets for Synergistic Photothermal and Photodynamic Antibacterial Therapy. Nanomaterials 2021, 11, 3064. [Google Scholar] [CrossRef] [PubMed]
- Jin, F.; Liu, D.; Xu, X.; Ji, J.; Du, Y. Nanomaterials-based photodynamic therapy with combined treatment improves antitumor efficacy through boosting immunogenic cell death. Int. J. Nanomed. 2021, 16, 4693–4712. [Google Scholar] [CrossRef]
- Husni, P.; Shin, Y.; Kim, J.C.; Kang, K.; Lee, E.S.; Youn, Y.S.; Rusdiana, T.; Oh, K.T. Photo-Based Nanomedicines Using Polymeric Systems in the Field of Cancer Imaging and Therapy. Biomedicines 2020, 8, 618. [Google Scholar] [CrossRef] [PubMed]
- Yadav, D.; Malviya, R. Novel nanomaterials as photo-activated cancer diagnostics and therapy. Med. Adv. 2023, 1, 190–209. [Google Scholar] [CrossRef]
- Moreno-Lanceta, A.; Medrano-Bosch, M.; Melgar-Lesmes, P. Single-Walled Carbon Nanohorns as Promising Nanotube-Derived Delivery Systems to Treat Cancer. Pharmaceutics 2020, 12, 850. [Google Scholar] [CrossRef] [PubMed]
- Montiel Schneider, M.G.; Martín, M.J.; Otarola, J.; Vakarelska, E.; Simeonov, V.; Lassalle, V.; Nedyalkova, M. Biomedical Applications of Iron Oxide Nanoparticles: Current Insights Progress and Perspectives. Pharmaceutics 2022, 14, 204. [Google Scholar] [CrossRef] [PubMed]
- Aboeleneen, S.B.; Scully, M.A.; Harris, J.C.; Sterin, E.H.; Day, E.S. Membrane-wrapped nanoparticles for photothermal cancer therapy. Nano Converg. 2022, 9, 37. [Google Scholar] [CrossRef] [PubMed]
- Truong, D.H.; Tran, P.T.T.; Tran, T.H. Nanoparticles as carriers of photosensitizers to improve photodynamic therapy in cancer. Pharm. Dev. Technol. 2024, 29, 221–235. [Google Scholar] [CrossRef]
- Li, S.; Yang, S.; Liu, C.; He, J.; Li, T.; Fu, C.; Shao, H. Enhanced photothermal-photodynamic therapy by indocyanine green and curcumin-loaded layered MoS2 hollow spheres via inhibition of P-glycoprotein. Int. J. Nanomed. 2021, 16, 433–442. [Google Scholar] [CrossRef] [PubMed]
- Vaidya, S.P.; Gadre, S.; Kamisetti, R.T.; Patra, M. Challenges and opportunities in the development of metal-based anticancer theranostic agents. Biosci. Rep. 2022, 42, BSR20212160. [Google Scholar] [CrossRef] [PubMed]
- Alavi, M.; Webster, T.J.; Li, L. Theranostic safe quantum dots for anticancer and bioimaging applications. Micro Nano Bio Asp. 2022, 1, 1–11. [Google Scholar] [CrossRef]
- Lv, Z.; Jin, L.; Gao, W.; Cao, Y.; Zhang, H.; Xue, D.; Zhang, H. Novel YOF-based theranostic agents with a cascade effect for NIR-II fluorescence imaging and synergistic starvation/photodynamic therapy of orthotopic gliomas. ACS Appl. Mater. Interfaces 2022, 14, 30523–30532. [Google Scholar] [CrossRef] [PubMed]
- Gao, J.; Jiang, H.; Chen, P.; Zhang, R.; Liu, N. Photosensitizer-based small molecule theranostic agents for tumor-targeted monitoring and phototherapy. Bioorg. Chem. 2023, 136, 106554. [Google Scholar] [CrossRef] [PubMed]
- Amini, S.M.; Rezayat, S.M.; Dinarvand, R.; Kharrazi, S.; Jaafari, M.R. Gold cluster encapsulated liposomes: Theranostic agent with stimulus triggered release capability. Med. Oncol. 2023, 40, 126. [Google Scholar] [CrossRef] [PubMed]
- Abolhasani Zadeh, F.; Shahhosseini, E.; Rasoolzadegan, S.; Özbolat, G.; Farahbod, F. Au nanoparticles in the diagnosis and treatment of ovarian cancer: A new horizon in the personalized medicine. Nanomed. Res. J. 2022, 7, 1–18. [Google Scholar] [CrossRef]
- Shrestha, B.; Tang, L.; Hood, R.L. Nanotechnology for Personalized Medicine. In Nanomedicine; Springer Nature: Singapore, 2023; pp. 555–603. [Google Scholar] [CrossRef]
- Hosseini, S.M.; Mohammadnejad, J.; Salamat, S.; Zadeh, Z.B.; Tanhaei, M.; Ramakrishna, S. Theranostic polymeric nanoparticles as a new approach in cancer therapy and diagnosis: A review. Mater. Today Chem. 2023, 29, 101400. [Google Scholar] [CrossRef]
- Liu, B.; Sun, L.; Lu, X.; Yang, Y.; Peng, H.; Sun, Z.; Chu, H. Real-time drug release monitoring from pH-responsive CuS-encapsulated metal–organic frameworks. RSC Adv. 2022, 12, 11119–11127. [Google Scholar] [CrossRef] [PubMed]
- Zhao, Y.; Pan, Y.; Zou, K.; Lan, Z.; Cheng, G.; Mai, Q.; Yu, G. Biomimetic manganese-based theranostic nanoplatform for cancer multimodal imaging and twofold immunotherapy. Bioact. Mater. 2023, 19, 237–250. [Google Scholar] [CrossRef]
- Tiwari, R.; Tiwari, G.; Parashar, P. Theranostics Applications of Functionalized Magnetic Nanoparticles. In Multifunctional and Targeted Theranostic Nanomedicines; Jain, K., Jain, N.K., Eds.; Springer: Singapore, 2023; pp. 361–382. [Google Scholar] [CrossRef]
- Asil, S.M.; Guerrero, E.D.; Bugarini, G.; Cayme, J.; De Avila, N.; Garcia, J.; Hernandez, A.; Mecado, J.; Madero, Y.; Moncayo, F.; et al. Theranostic applications of multifunctional carbon nanomaterials. VIEW 2023, 4, 20220056. [Google Scholar] [CrossRef]
- Mirahadi, M.; Ghanbarzadeh, S.; Ghorbani, M.; Gholizadeh, A.; Hamishehkar, H. A review on the role of lipid-based nanoparticles in medical diagnosis and imaging. Ther. Deliv. 2018, 9, 557–569. [Google Scholar] [CrossRef] [PubMed]
- Silva, C.O.; Pinho, J.O.; Lopes, J.M.; Almeida, A.J.; Gaspar, M.M.; Reis, C. Current Trends in Cancer Nanotheranostics: Metallic, Polymeric, and Lipid-Based Systems. Pharmaceutics 2019, 11, 22. [Google Scholar] [CrossRef] [PubMed]
- Marshall, S.K.; Angsantikul, P.; Pang, Z.; Nasongkla, N.; Hussen, R.S.D.; Thamphiwatana, S.D. Biomimetic Targeted Theranostic Nanoparticles for Breast Cancer Treatment. Molecules 2022, 27, 6473. [Google Scholar] [CrossRef]
- Liu, Y.; Zhu, S.; Gu, Z.; Chen, C.; Zhao, Y. Toxicity of manufactured nanomaterials. Particuology 2022, 69, 31–48. [Google Scholar] [CrossRef]
- Li, X.; Wang, L.; Fan, Y.; Feng, Q.; Cui, F.Z. Biocompatibility and toxicity of nanoparticles and nanotubes. J. Nanomater. 2012, 2012, 6. [Google Scholar] [CrossRef]
- Kessler, A.; Hedberg, J.; Blomberg, E.; Odnevall, I. Reactive Oxygen Species Formed by Metal and Metal Oxide Nanoparticles in Physiological Media—A Review of Reactions of Importance to Nanotoxicity and Proposal for Categorization. Nanomaterials 2022, 12, 1922. [Google Scholar] [CrossRef]
- Biswas, A.; Kar, U.; Jana, N.R. Cytotoxicity of ZnO nanoparticles under dark conditions via oxygen vacancy dependent reactive oxygen species generation. Phys. Chem. Chem. Phys. 2022, 24, 13965–13975. [Google Scholar] [CrossRef]
- Chen, Q.; Riviere, J.E.; Lin, Z. Toxicokinetics, dose–response, and risk assessment of nanomaterials: Methodology, challenges, and future perspectives. Wiley Interdiscip. Rev. Nanomed. Nanobiotechnol. 2022, 14, e1808. [Google Scholar] [CrossRef]
- Liu, J.; Liu, Z.; Pang, Y.; Zhou, H. The interaction between nanoparticles and immune system: Application in the treatment of inflammatory diseases. J. Nanobiotechnol. 2022, 20, 127. [Google Scholar] [CrossRef] [PubMed]
- Ejazi, S.A.; Louisthelmy, R.; Maisel, K. Mechanisms of nanoparticle transport across intestinal tissue: An oral delivery perspective. ACS Nano 2023, 17, 13044–13061. [Google Scholar] [CrossRef] [PubMed]
- Rao, S.V.; Anusha, L.; Rathan, B.H.; Soniya, S.; Padmalatha, K. Nanopharmaceutics: A Novel Drug Delivery Technology. J. Popul. Ther. Clin. Pharmacol. 2023, 30, 888–903. [Google Scholar] [CrossRef]
- Ali, F.; Neha, K.; Parveen, S. Current regulatory landscape of nanomaterials and nanomedicines: A global perspective. J. Drug Deliv. Sci. Technol. 2023, 80, 104118. [Google Scholar] [CrossRef]
- De Jong, W.H.; Geertsma, R.E.; Borchard, G. Regulatory safety evaluation of nanomedical products: Key issues to refine. Drug Deliv. Transl. Res. 2022, 12, 2042–2047. [Google Scholar] [CrossRef] [PubMed]
- Dri, D.A.; Rinaldi, F.; Carafa, M.; Marianecci, C. Nanomedicines and nanocarriers in clinical trials: Surfing through regulatory requirements and physico-chemical critical quality attributes. Drug Deliv. Transl. Res. 2023, 13, 757–769. [Google Scholar] [CrossRef] [PubMed]
- Berkner, S.; Schwirn, K.; Voelker, D. Too advanced for assessment? Advanced materials, nanomedicine and the environment. Environ. Sci. Eur. 2022, 34, 71. [Google Scholar] [CrossRef] [PubMed]
- Herdiana, Y.; Wathoni, N.; Shamsuddin, S.; Muchtaridi, M. Scale-up polymeric-based nanoparticles drug delivery systems: Development and challenges. OpenNano 2022, 7, 100048. [Google Scholar] [CrossRef]
- Yadav, H.K.; Al mohammedawi, F.; Abujarad, R.J. Applications and Prospects of Nanopharmaceuticals Delivery. In Advances in Novel Formulations for Drug Delivery; Wiley, Scrivener Publishing LLC: Beverly, MA, USA, 2023; pp. 45–66. [Google Scholar] [CrossRef]
- Souza, P.B.D.; Ramos, D.F.; Gubert, P.G.; Cigognini, E.; Primo, F.T. Nanodrug research and development: A bioethical approach. Rev. Bioét. 2023, 31, e3014PT. [Google Scholar] [CrossRef]
- Panghal, A.; Flora, S.J.S. Toxicity Evaluation of Nanomedicine. In Recent Advances in Therapeutic Drug Monitoring and Clinical Toxicology; Springer International Publishing: Cham, Switzerland, 2022; pp. 323–345. [Google Scholar] [CrossRef]
- Medhi, B.; Sewal, R.K. Ecopharmacovigilance: An issue urgently to be addressed. Indian J. Pharmacol. 2012, 44, 547–549. [Google Scholar] [CrossRef] [PubMed]
- Murray, S.R. Ecopharmacovigilance: A drug company perspective. In Proceedings of the 10th Annual Meeting of the International Society of Pharmacovigilance, Accra, Ghana, 3–6 November 2010. [Google Scholar]
- Wang, J.; Zhang, M.Y.; Liu, J.; Hu, X.M.; He, B.S. Using a targeted ecopharmacovigilance intervention to control antibiotic pollution in a rural aquatic environment. Sci Total Environ. 2019, 696, 134007. [Google Scholar] [CrossRef] [PubMed]
- Priya, D.P.; Prema v, N.; Mounika, T.; Karishma, K.; Himaja, G.; Vani, B. A Review on Eco-Pharmacovigilance. IJPBA 2023, 11, 65–70. [Google Scholar]
- Velo, G.P. Why ecopharmacovigilance. Drug Saf. 2007, 30, 919. [Google Scholar] [CrossRef] [PubMed]
- Akhtar, A. The flaws and human harms of animal experimentation. Camb. Q. Healthc. Ethics CQ Int. J. Healthc. Ethics Comm. 2015, 24, 407–419. [Google Scholar] [CrossRef] [PubMed]
- Russell, W.M.; Burch, R.L. The Principles of Humane Experimental Technique; Universities Federation for Animal Welfare: Wheathampstead, UK, 1992; ISBN 9780900767784. [Google Scholar]
- Doke, S.K.; Dhawale, S.C. Alternatives to animal testing: A review. Saudi Pharm. J. 2015, 23, 223–229. [Google Scholar] [CrossRef] [PubMed]
- Banks, R.E. The 4th R of Research. Contemp. Top. Lab. Anim. Sci. 1995, 34, 43. [Google Scholar] [PubMed]
- Husain, A.; Meenakshi, D.U.; Ahmad, A.; Shrivastava, N.; Khan, S.A. A Review on Alternative Methods to Experimental Animals in Biological Testing: Recent Advancement and Current Strategies. J. Pharm. Bioallied Sci. 2023, 15, 165–171. [Google Scholar] [CrossRef] [PubMed]
- Arora, T.; Mehta, A.K.; Joshi, V.; Mehta, K.D.; Rathor, N.; Mediratta, P.K.; Sharma, K.K. Substitute of Animals in Drug Research: An Approach Towards Fulfillment of 4R’s. Indian J. Pharm. Sci. 2011, 73, 1–6. [Google Scholar] [CrossRef] [PubMed]
- Harris, A.F.; Lacombe, J.; Zenhausern, F. The Emerging Role of Decellularized Plant-Based Scaffolds as a New Biomaterial. Int. J. Mol. Sci. 2021, 22, 12347. [Google Scholar] [CrossRef] [PubMed]
- Predeina, A.L.; Prilepskii, A.Y.; de Zea Bermudez, V.; Vinogradov, V.V. Bioinspired In Vitro Brain Vasculature Model for Nanomedicine Testing Based on Decellularized Spinach Leaves. Nano Lett. 2021, 21, 9853–9861. [Google Scholar] [CrossRef] [PubMed]
- Sutariya, V.B.; Pathak, Y. (Eds.) Biointeractions of Nanomaterials; CRC Press: Boca Raton, FL, USA, 2014. [Google Scholar] [CrossRef]
- Palombo, M.; Deshmukh, M.; Myers, D.; Gao, J.; Szekely, Z.; Sinko, P.J. Pharmaceutical and toxicological properties of engineered nanomaterials for drug delivery. Annu. Rev. Pharmacol. Toxicol. 2014, 54, 581–598. [Google Scholar] [CrossRef] [PubMed]
- Valavanidis, A.; Vlachogianni, T. Engineered nanomaterials for pharmaceutical and biomedical products new trends, benefits and opportunities. Pharm. Bioprocess. 2016, 4, 13–24. [Google Scholar] [CrossRef]
- Mast, M.-P.; Modh, H.; Champanhac, C.; Wang, J.-W.; Storm, G.; Krämer, J.; Mailänder, V.; Pastorin, G.; Wacker, M.G. Nanomedicine at the crossroads—A quick guide for IVIVC. Adv. Drug Deliv. Rev. 2021, 179, 113829. [Google Scholar] [CrossRef] [PubMed]
- Farjadian, F.; Ghasemi, A.; Gohari, O.; Roointan, A.; Karimi, M.; Hamblin, M.R. Nanopharmaceuticals and nanomedicines currently on the market: Challenges and opportunities. Nanomedicine 2019, 14, 93–126. [Google Scholar] [CrossRef] [PubMed]
- Zhu, W.; Wei, Z.; Han, C.; Weng, X. Nanomaterials as Promising Theranostic Tools in Nanomedicine and Their Applications in Clinical Disease Diagnosis and Treatment. Nanomaterials 2021, 11, 3346. [Google Scholar] [CrossRef] [PubMed]
- Marcato, P.D.; Nelson Durán, N. New Aspects of Nanopharmaceutical Delivery Systems. J. Nanosci. Nanotechnol. 2008, 8, 2216–2229. [Google Scholar] [CrossRef]
- Choi, Y.H.; Han, H.-K. Nanomedicines: Current status and future perspectives in aspect of drug delivery and pharmacokinetics. J. Pharm. Investig. 2018, 48, 43–60. [Google Scholar] [CrossRef] [PubMed]
- Shan, X.; Gong, X.; Li, J.; Wen, J.; Li, Y.; Zhang, Z. Current approaches of nanomedicines in the market and various stage of clinical translation. Acta Pharm. Sin. B 2022, 12, 3028–3048. [Google Scholar] [CrossRef] [PubMed]
- Prakash, S. Nano-based drug delivery system for therapeutics: A comprehensive review. Biomed. Phys. Eng. Express 2023, 9, 052002. [Google Scholar] [CrossRef] [PubMed]
- Rivera, G.P.; Hühn, D.; del Mercato, L.L.; Sasse, D.; Parak, W.J. Nanopharmacy: Inorganic nanoscale devices as vectors and active compounds. Pharmacol. Res. 2010, 62, 115–125. [Google Scholar] [CrossRef] [PubMed]
- Babaie, S.; Taghvimi, A.; Hong, J.H.; Hamishehkar, H.; An, S.; Kim, K.H. Recent advances in pain management based on nanoparticle technologies. J. Nanobiotechnol. 2022, 20, 290. [Google Scholar] [CrossRef]
- Jia, Y.; Jiang, Y.; He, Y.; Zhang, W.; Zou, J.; Magar, K.T.; Boucetta, H.; Teng, C.; He, W. Approved Nanomedicine against Diseases. Pharmaceutics 2023, 15, 774. [Google Scholar] [CrossRef] [PubMed]
- Petrović, S.; Ilić-Stojanović, S.; Tačić, A.; Nikolić, L.; Nikolić, V. Vesicular Drug Carriers as Delivery Systems. In Nanoconjugate Nanocarriers for Drug Delivery; Apple Academic Press: Palm Bay, FL, USA, 2018; pp. 141–174. [Google Scholar] [CrossRef]
- Pokropivny, V.V.; Skorokhod, V.V. New dimensionality classifications of nanostructures. Phys. E Low-Dimens. Syst. Nanostruct. 2008, 40, 2521–2525. [Google Scholar] [CrossRef]
- Joudeh, N.; Linke, D. Nanoparticle classification, physicochemical properties, characterization, and applications: A comprehensive review for biologists. J. Nanobiotechnol. 2022, 20, 262. [Google Scholar] [CrossRef] [PubMed]
- Puri, A.; Loomis, K.; Smith, B.; Lee, J.H.; Yavlovich, A.; Heldman, E.; Blumenthal, R. Lipid-based nanoparticles as pharmaceutical drug carriers: From concepts to clinic. Crit. Rev. Ther. Drug Carr. Syst. 2009, 26, 523–580. [Google Scholar] [CrossRef] [PubMed]
- Halwani, A.A. Development of Pharmaceutical Nanomedicines: From the Bench to the Market. Pharmaceutics 2022, 14, 106. [Google Scholar] [CrossRef] [PubMed]
- Li, M.; Xin, M.; Guo, C.; Lin, G.; Wu, X. New nanomicelle curcumin formulation for ocular delivery: Improved stability, solubility, and ocular anti-inflammatory treatment. Drug Dev. Ind. Pharm. 2017, 43, 1846–1857. [Google Scholar] [CrossRef] [PubMed]
- Rather, S.-u.; Islam, M.S.; Bamufleh, H.S.; Alhumade, H.; Taimoor, A.A.; Saeed, U.; Sulaimon, A.A.; Hoque, M.A.; Alalayah, W.M.; Shariff, A.M. Effects of alcohols and temperature on association, micellar parameters, and energetics of mixture of cetylpyridinium bromide and polyvinyl alcohol. J. Mol. Liq. 2023, 380, 121722. [Google Scholar] [CrossRef]
- Asyikin binti Abdul Aziz, Z.; Ahmad, A.; Hamidah Mohd-Setapar, S.; Hassan, H.; Lokhat, D.; Amjad Kamal, M.; Md Ashraf, G. Recent Advances in Drug Delivery of Polymeric Nano-Micelles. Curr. Drug Metab. 2017, 18, 16–29. [Google Scholar] [CrossRef] [PubMed]
- Vaishya, R.D.; Khurana, V.; Patel, S.; Mitra, A.K. Controlled ocular drug delivery with nanomicelles. Wiley Interdiscip. Rev. Nanomed. Nanobiotechnol. 2014, 6, 422–437. [Google Scholar] [CrossRef]
- Rehan, F.; Ahemad, N.; Gupta, M. Casein nanomicelle as an emerging biomaterial—A comprehensive review. Colloids Surf. B Biointerfaces 2019, 179, 280–292. [Google Scholar] [CrossRef] [PubMed]
- Rojas-Candelas, L.E.; Chanona-Pérez, J.J.; Méndez, J.V.M.; Morales-Hernández, J.A.; Benavides, H.A.C. Characterization of Structural Changes of Casein Micelles at Different pH Using Microscopy and Spectroscopy Techniques. Microsc. Microanal. 2022, 28, 527–536. [Google Scholar] [CrossRef] [PubMed]
- Khatun, S.; Appidi, T.; Rengan, A.K. Casein nanoformulations-Potential biomaterials in theranostics. Food Biosci. 2022, 50, 102200. [Google Scholar] [CrossRef]
- Ma, Y.; Liang, X.; Tong, S.; Bao, G.; Ren, Q.; Dai, Z. Gold Nanoshell Nanomicelles for Potential Magnetic Resonance Imaging, Light-Triggered Drug Release, and Photothermal Therapy. Adv. Funct. Mater. 2012, 23, 815–822. [Google Scholar] [CrossRef]
- Wen, L.J.; Wang, Y.S.; Zhang, J. Nano-gold micelles loaded Dox and Elacridar for reversing drug resistance of breast cancer. IET Nanobiotechnol. 2023, 17, 49–60. [Google Scholar] [CrossRef] [PubMed]
- Uchida, S.; Itaka, K.; Uchida, H.; Hayakawa, K.; Ogata, T.; Ishii, T.; Fukushima, S.; Osada, K.; Kataoka, K. In vivo messenger RNA introduction into the central nervous system using polyplex nanomicelle. PLoS ONE 2013, 8, e56220. [Google Scholar] [CrossRef] [PubMed]
- Foo, W.; Cseresnyés, Z.; Rössel, C.; Teng, Y.; Ramoji, A.; Chi, M.; Hauswald, W.; Huschke, S.; Stephanie Hoeppener, S.; Jürgen, P.; et al. Tuning the corona-core ratio of polyplex micelles for selective oligonucleotide delivery to hepatocytes or hepatic immune cells. Biomaterials 2023, 294, 122016. [Google Scholar] [CrossRef]
- Du, X.; Yada, E.; Terai, Y.; Takahashi, T.; Nakanishi, H.; Tanaka, H.; Akita, H.; Itaka, K. Comprehensive Evaluation of Lipid Nanoparticles and Polyplex Nanomicelles for Muscle-Targeted mRNA Delivery. Pharmaceutics 2023, 15, 2291. [Google Scholar] [CrossRef]
- Cesur, H.; Rubinstein, I.; Pai, A.; Onyüksel, H. Self-associated indisulam in phospholipid-based nanomicelles: A potential nanomedicine for cancer. Nanomed. Nanotechnol. Biol. Med. 2009, 5, 178–183. [Google Scholar] [CrossRef] [PubMed]
- Chakraborty, A.; Dhar, P. Phospholipid-Based. In Handbook of Nanotechnology in Nutraceuticals; CRC Press: Boca Raton, FL, USA, 2022; p. 183. [Google Scholar] [CrossRef]
- Rajablou, K.; Attar, H.; Sadjady, S.K.; Heydarinasab, A. DSPC based polymeric micelles loaded with Amphotericin B: Synthesis, characterization, and in vitro study. Nanomed. Res. J. 2023, 8, 37–49. [Google Scholar] [CrossRef]
- Guo, C.; Zhang, Y.; Yang, Z.; Li, M.; Li, F.; Cui, F.; Liu, T.; Shi, W.; Wu, X. Nanomicelle formulation for topical delivery of cyclosporine A into the cornea: In vitro mechanism and in vivo permeation evaluation. Sci. Rep. 2015, 5, 12968. [Google Scholar] [CrossRef]
- Zhang, T.; Wei, C.; Wu, X.; Zhang, S.; Duan, F.; Qi, X.; Shi, W.; Gao, H. Characterization and Evaluation of Rapamycin-Loaded Nano-Micelle Ophthalmic Solution. J. Funct. Biomater. 2023, 14, 49. [Google Scholar] [CrossRef] [PubMed]
- Cai, R.; Zhang, L.; Chi, H. Recent development of polymer nanomicelles in the treatment of eye diseases. Front. Bioeng. Biotechnol. 2023, 11, 1246974. [Google Scholar] [CrossRef] [PubMed]
- Khiev, D.; Mohamed, Z.A.; Vichare, R.; Paulson, R.; Bhatia, S.; Mohapatra, S.; Lobo, G.P.; Valapala, M.; Kerur, N.; Passaglia, C.L.; et al. Emerging Nano-Formulations and Nanomedicines Applications for Ocular Drug Delivery. Nanomaterials 2021, 11, 173. [Google Scholar] [CrossRef] [PubMed]
- Alizadeh, F.; Javadi, M.; Karami, A.A.; Gholaminejad, F.; Kavianpour, M.; Haghighian, H.K. Curcumin nanomicelle improves semen parameters, oxidative stress, inflammatory biomarkers, and reproductive hormones in infertile men: A randomized clinical trial. Phytother. Res. 2018, 32, 514–521. [Google Scholar] [CrossRef] [PubMed]
- Farhoudi, L.; Kesharwani, P.; Majeed, M.; Johnston, T.P.; Sahebkar, A. Polymeric nanomicelles of curcumin: Potential applications in cancer. Int. J. Pharm. 2022, 617, 121622. [Google Scholar] [CrossRef] [PubMed]
- Bakhshi, M.; Mahboubi, A.; Jaafari, M.R.; Ebrahimi, F.; Tofangchiha, M.; Alizadeh, A. Comparative efficacy of 1% curcumin nanomicelle gel and 2% curcumin gel for treatment of recurrent aphthous stomatitis: A double-blind randomized clinical trial. J. Evid.-Based Dent. Pract. 2022, 22, 101708. [Google Scholar] [CrossRef] [PubMed]
- Piazzini, V.; D’Ambrosio, M.; Luceri, C.; Cinci, L.; Landucci, E.; Bilia, A.R.; Bergonzi, M.C. Formulation of Nanomicelles to Improve the Solubility and the Oral Absorption of Silymarin. Molecules 2019, 24, 1688. [Google Scholar] [CrossRef] [PubMed]
- Sharma, A.; Arora, K.; Mohapatra, H.; Sindhu, R.K.; Bulzan, M.; Cavalu, S.; Paneshar, G.; Elansary, H.O.; El-Sabrout, A.M.; Mahmoud, E.A.; et al. Supersaturation-Based Drug Delivery Systems: Strategy for Bioavailability Enhancement of Poorly Water-Soluble Drugs. Molecules 2022, 27, 2969. [Google Scholar] [CrossRef] [PubMed]
- Ge, W.; Li, D.; Chen, M.; Wang, X.; Liu, S.; Sun, R. Characterization and antioxidant activity of β-carotene loaded chitosan-graft-poly(lactide) nanomicelles. Carbohydr. Polym. 2015, 117, 169–176. [Google Scholar] [CrossRef]
- Pourjavadi, A.; Kashani, F.B.; Doroudian, M.; Amin, S.S. Synthesis and characterization of stimuli responsive micelles from chitosan, starch, and alginate based on graft copolymers with polylactide-poly (methacrylic acid) and polylactide-poly [2 (dimethyl amino) ethyl methacrylate] side chains. Int. J. Biol. Macromol. 2023, 253, 127170. [Google Scholar] [CrossRef] [PubMed]
- Jangid, A.K.; Patel, K.; Jain, P.; Patel, S.; Gupta, N.; Pooja, D.; Kulhari, H. Inulin-pluronic-stearic acid based double folded nanomicelles for pH-responsive delivery of resveratrol. Carbohydr. Polym. 2020, 247, 116730. [Google Scholar] [CrossRef] [PubMed]
- Kar, A.; Rout, S.R.; Singh, V.; Greish, K.; Sahebkar, A.; Abourehab, M.A.; Kesharwani, P.; Dandela, R. Triblock polymeric micelles as an emerging nanocarrier for drug delivery. In Polymeric Micelles for Drug Delivery; Woodhead Publishing: Sawston, UK, 2022; pp. 561–590. [Google Scholar] [CrossRef]
- Li, Z.; Li, J.; Zhu, L.; Zhang, Y.; Zhang, J.; Yao, L.; Liang, D.; Wang, L. Celastrol nanomicelles attenuate cytokine secretion in macrophages and inhibit macrophage-induced corneal neovascularization in rats. Int. J. Nanomed. 2016, 11, 6135–6148. [Google Scholar] [CrossRef] [PubMed]
- Zhang, Y.; Liu, R.; Li, C.; Shi, L.; Guo, Z.; Zhu, L.; Wen, L.; Li, J.; Li, Z. Celastrol-based nanomedicine hydrogels eliminate posterior capsule opacification. Nanomedicine 2022, 17, 1449–1461. [Google Scholar] [CrossRef] [PubMed]
- Waheed, I.; Ali, A.; Tabassum, H.; Khatoon, N.; Lai, W.F.; Zhou, X. Lipid-based nanoparticles as drug delivery carriers for cancer therapy. Front. Oncol. 2024, 14, 1296091. [Google Scholar] [CrossRef] [PubMed]
- Loo, Y.S.; Zahid, N.I.; Madheswaran, T.; Azmi, I.D.M. Recent advances in the development of multifunctional lipid-based nanoparticles for co-delivery, combination treatment strategies, and theranostics in breast and lung cancer. J. Drug Deliv. Sci. Technol. 2022, 71, 103300. [Google Scholar] [CrossRef]
- Ahmed, S.; Nikolov, Z.; Wunder, S.L. Effect of curvature on nanoparticle supported lipid bilayers investigated by Raman spectroscopy. J. Phys. Chem. B 2011, 115, 13181–13190. [Google Scholar] [CrossRef] [PubMed]
- Qizilbash, F.; Sartaj, A.; Qamar, Z.; Kumar, S.; Imran, M.; Mohammed, Y.; Ali, J.; Baboota, S.; Ali, A. Nanotechnology revolutionises breast cancer treatment: Harnessing lipid-based nanocarriers to combat cancer cells. J. Drug Target. 2023, 31, 794–816. [Google Scholar] [CrossRef] [PubMed]
- Nel, J.; Elkhoury, K.; Velot, É.; Bianchi, A.; Acherar, S.; Francius, G.; Tamayol, A.; Grandemange, S.; Arab-Tehrany, E. Functionalized liposomes for targeted breast cancer drug delivery. Bioact. Mater. 2023, 24, 401–437. [Google Scholar] [CrossRef] [PubMed]
- Gbian, D.L.; Omri, A. Lipid-Based Drug Delivery Systems for Diseases Managements. Biomedicines 2022, 10, 2137. [Google Scholar] [CrossRef]
- Petrović, S.M.; Tugulea, L.; Marković, D.Z.; Barbinta-Patrascu, M. Chlorophyll a and chlorophyllide a inside liposomes made of saturated and unsaturated lipids: A possible impact of the lipids microenvironment. Acta Period. Technol. 2014, 45, 215–227. [Google Scholar] [CrossRef]
- Han, X.; Lu, Y.; Xu, Z.; Chu, Y.; Ma, X.; Wu, H.; Zou, B.; Zhou, G. Anionic liposomes prepared without organic solvents for effective siRNA delivery. IET Nanobiotechnol. 2023, 17, 269–280. [Google Scholar] [CrossRef] [PubMed]
- Petrovic, S.M.; Barbinta-Patrascu, M.-E. Organic and Biogenic Nanocarriers as Bio-Friendly Systems for Bioactive Compounds’ Delivery: State-of-the Art and Challenges. Materials 2023, 16, 7550. [Google Scholar] [CrossRef] [PubMed]
- Wang, S.; Chen, Y.; Guo, J.; Huang, Q. Liposomes for Tumor Targeted Therapy: A Review. Int. J. Mol. Sci. 2023, 24, 2643. [Google Scholar] [CrossRef]
- Yan, W.; Leung, S.S.; To, K.K. Updates on the use of liposomes for active tumor targeting in cancer therapy. Nanomedicine 2020, 15, 303–318. [Google Scholar] [CrossRef]
- Vasdev, N.; Pawar, B.; Gupta, T.; Mhatre, M.; Tekade, R.K. A Bird’s Eye View of Various Cell-Based Biomimetic Nanomedicines for the Treatment of Arthritis. Pharmaceutics 2023, 15, 1150. [Google Scholar] [CrossRef]
- Xie, Q.; Liu, Y.; Long, Y.; Wang, Z.; Jiang, S.; Ahmed, R.; Daniyal, M.; Li, B.; Liu, B.; Wang, W. Hybrid-Cell Membrane-Coated Nanocomplex-Loaded Chikusetsusaponin IVa Methyl Ester for a Combinational Therapy against Breast Cancer Assisted by Ce6. Biomater. Sci. 2021, 9, 2991–3004. [Google Scholar] [CrossRef] [PubMed]
- D’Souza, S.E.; Ginsberg, M.H.; Plow, E.F. Arginyl-glycyl-aspartic acid (RGD): A cell adhesion motif. Trends Biochem. Sci. 1991, 16, 246–250. [Google Scholar] [CrossRef] [PubMed]
- Wang, X.; Guerrand, L.; Wu, B.; Li, X.; Boldon, L.; Chen, W.-R.; Liu, L. Characterizations of Polyamidoamine Dendrimers with Scattering Techniques. Polymers 2012, 4, 600–616. [Google Scholar] [CrossRef]
- Mittal, P.; Saharan, A.; Verma, R.; Altalbawy, F.M.A.; Alfaidi, M.A.; Batiha, G.E.; Akter, W.; Gautam, R.K.; Uddin, M.S.; Rahman, M.S. Dendrimers: A New Race of Pharmaceutical Nanocarriers. BioMed Res. Int. 2021, 2021, 8844030. [Google Scholar] [CrossRef] [PubMed]
- Crintea, A.; Motofelea, A.C.; Șovrea, A.S.; Constantin, A.-M.; Crivii, C.-B.; Carpa, R.; Duțu, A.G. Dendrimers: Advancements and Potential Applications in Cancer Diagnosis and Treatment—An Overview. Pharmaceutics 2023, 15, 1406. [Google Scholar] [CrossRef] [PubMed]
- Awasthi, K.; Srivastava, A.; Srivastava, O.N. Synthesis of carbon nanotubes. J. Nanosci. Nanotechnol. 2005, 5, 1616–1636. [Google Scholar] [CrossRef] [PubMed]
- Petrovic, D.; Seke, M.; Srdjenovic, B.; Djordjevic, A. Applications of Anti/Prooxidant Fullerenes in Nanomedicine along with Fullerenes Influence on the Immune System. J. Nanomater. 2015, 2015, 565638. [Google Scholar] [CrossRef]
- Ma, H.; Liang, X.J. Fullerenes as unique nanopharmaceuticals for disease treatment. Sci. China Chem. 2010, 53, 2233–2240. [Google Scholar] [CrossRef]
- Brant, J.; Lecoanet, H.; Wiesner, M.R. Aggregation and deposition characteristics of fullerene nanoparticles in aqueous systems. J. Nanoparticle Res. 2005, 7, 545–553. [Google Scholar] [CrossRef]
- Fernandes, N.B.; Shenoy, R.U.K.; Kajampady, M.K.; DCruz, C.E.M.; Shirodkar, R.K.; Kumar, L.; Verma, R. Fullerenes for the treatment of cancer: An emerging tool. Environ. Sci. Pollut. Res. Int. 2022, 29, 58607–58627. [Google Scholar] [CrossRef] [PubMed]
- Foldvari, M.; Bagonluri, M. Carbon nanotubes as functional excipients for nanomedicines: I. Pharmaceutical properties. Nanomedicine 2008, 4, 173–182. [Google Scholar] [CrossRef] [PubMed]
- Mostafavi, E.; Iravani, S.; Varma, R.S.; Khatami, M.; Rahbarizadeh, F. Eco-friendly synthesis of carbon nanotubes and their cancer theranostic applications. Mater. Adv. 2022, 3, 4765–4782. [Google Scholar] [CrossRef] [PubMed]
- Singh, A.K.; Yadav, T.P.; Pandey, B.; Gupta, V.; Singh, S.P. Engineering Nanomaterials for Smart Drug Release. Appl. Target. Nano Drugs Deliv. Syst. 2019, 411–449. [Google Scholar] [CrossRef]
- Qasim, M.; Clarkson, A.N.; Hinkley, S.F.R. Green Synthesis of Carbon Nanoparticles (CNPs) from Biomass for Biomedical Applications. Int. J. Mol. Sci. 2023, 24, 1023. [Google Scholar] [CrossRef] [PubMed]
- Scrivens, W.A.; Rawlett, A.M.; Tour, J.M. Preparative Benchtop Enrichment of C(60), C(70), and the Higher Fullerene Allotropes Using a Brominated Polystyrene Stationary Phase. J. Org. Chem. 1997, 62, 2310–2311. [Google Scholar] [CrossRef] [PubMed]
- Curcio, M.; Cirillo, G.; Saletta, F.; Michniewicz, F.; Nicoletta, F.P.; Vittorio, O.; Hampel, S.; Iemma, F. Carbon Nanohorns as Effective Nanotherapeutics in Cancer Therapy. C 2021, 7, 3. [Google Scholar] [CrossRef]
- Negrescu, A.M.; Killian, M.S.; Raghu, S.N.V.; Schmuki, P.; Mazare, A.; Cimpean, A. Metal Oxide Nanoparticles: Review of Synthesis, Characterization and Biological Effects. J. Funct. Biomater. 2022, 13, 274. [Google Scholar] [CrossRef] [PubMed]
- Singh, D. Cyanobacteria as a source of nanoparticle: Application and future projections. In Advances in Cyanobacterial Biology; Academic Press: Cambridge, MA, USA, 2020; pp. 319–331. [Google Scholar] [CrossRef]
- Jamkhande, P.G.; Ghule, N.W.; Bamer, A.H.; Kalaskar, M.G. Metal nanoparticles synthesis: An overview on methods of preparation, advantages and disadvantages, and applications. J. Drug Deliv. Sci. Technol. 2019, 53, 101174. [Google Scholar] [CrossRef]
- Soenen, S.J.; De Cuyper, M. Assessing iron oxide nanoparticle toxicity in vitro: Current status and future prospects. Nanomedicine 2010, 5, 1261–1275. [Google Scholar] [CrossRef] [PubMed]
- Ren, X.; Chen, H.; Yang, V.; Sun, D. Iron oxide nanoparticle-based theranostics for cancer imaging and therapy. Front. Chem. Sci. Eng. 2014, 8, 253–264. [Google Scholar] [CrossRef]
- Wang, N.; Chen, L.; Huang, W.; Gao, Z.; Jin, M. Current Advances of Nanomaterial-Based Oral Drug Delivery for Colorectal Cancer Treatment. Nanomaterials 2024, 14, 557. [Google Scholar] [CrossRef] [PubMed]
- Tian, C.; Tang, Z.; Hou, Y.; Mushtaq, A.; Naz, S.; Yu, Z.; Farheen, J.; Iqbal, M.Z.; Kong, X. Facile Synthesis of Multifunctional Magnetoplasmonic Au-MnO Hybrid Nanocomposites for Cancer Theranostics. Nanomaterials 2022, 12, 1370. [Google Scholar] [CrossRef]
- Mushtaq, A.; Zhang, H.; Cui, M.; Lin, X.; Huang, S.; Tang, Z.; Hou, Y.; Iqbal, M.Z.; Kong, X. ROS-responsive chlorin e6 and silk fibroin loaded ultrathin magnetic hydroxyapatite nanorods for T1-magnetic resonance imaging guided photodynamic therapy in vitro. Colloids Surf. A Physicochem. Eng. Asp. 2023, 656, 130513. [Google Scholar] [CrossRef]
- Watanabe, A.; Kajita, M.; Kim, J.; Kanayama, A.; Takahashi, K.; Mashino, T.; Miyamoto, Y. In vitro free radical scavenging activity of platinum nanoparticles. Nanotechnology 2009, 20, 455105. [Google Scholar] [CrossRef] [PubMed]
- Yusof, F.; Ismail, N.A.S. Antioxidants effects of platinum nanoparticles: A potential alternative treatment to lung diseases. J. Appl. Pharm. Sci. 2015, 5, 140–145. [Google Scholar] [CrossRef]
- Brown, S.D.; Nativo, P.; Smith, J.A.; Stirling, D.; Edwards, P.R.; Venugopal, B.; Wheate, N.J. Gold nanoparticles for the improved anticancer drug delivery of the active component of oxaliplatin. J. Am. Chem. Soc. 2010, 132, 4678–4684. [Google Scholar] [CrossRef] [PubMed]
- El-Sayed, H.; Morad, M.Y.; Sonbol, H.; Hammam, O.A.; Abd El-Hameed, R.M.; Ellethy, R.A.; Ibrahim, A.M.; Hamada, M.A. Myco-Synthesized Selenium Nanoparticles as Wound Healing and Antibacterial Agent: An In Vitro and In Vivo Investigation. Microorganisms 2023, 11, 2341. [Google Scholar] [CrossRef] [PubMed]
- Skalickova, S.; Milosavljevic, V.; Cihalova, K.; Horky, P.; Richtera, L.; Adam, V. Selenium nanoparticles as a nutritional supplement. Nutrition 2017, 33, 83–90. [Google Scholar] [CrossRef] [PubMed]
- Song, M.; Liu, N.; He, L.; Liu, G.; Ling, D.; Su, X.; Sun, X. Porous hollow palladium nanoplatform for imaging-guided trimodal chemo-, photothermal-, and radiotherapy. Nano Res. 2018, 11, 2796–2808. [Google Scholar] [CrossRef]
- Phan, T.T.V.; Huynh, T.C.; Manivasagan, P.; Mondal, S.; Oh, J. An up-to-date review on biomedical applications of palladium nanoparticles. Nanomaterials 2020, 10, 66. [Google Scholar] [CrossRef] [PubMed]
- Pranati, T.; Anitha, R.; Rajeshkumar, S.; Lakshmi, T. Preparation of silver nanoparticles using nutmeg oleoresin and its antimicrobial activity against oral pathogens. Res. J. Pharm. Technol. 2019, 12, 2799–2803. [Google Scholar] [CrossRef]
- Khatami, M.; Mortazavi, S.M.; Kishani-Farahani, Z.; Amini, A.; Amini, E.; Heli, H. Biosynthesis of silver nanoparticles using pine pollen and evaluation of the antifungal efficiency. Iran. J. Biotechnol. 2017, 15, 95. [Google Scholar] [CrossRef] [PubMed]
- Jain, A.; Anitha, R.; Rajeshkumar, S.J.R.J. Anti inflammatory activity of Silver nanoparticles synthesised using Cumin oil. Res. J. Pharm. Technol. 2019, 12, 2790–2793. [Google Scholar] [CrossRef]
- Maity, D.; Gupta, U.; Saha, S. Biosynthesized metal oxide nanoparticles for sustainable agriculture: Next-generation nanotechnology for crop production, protection and management. Nanoscale 2022, 14, 13950–13989. [Google Scholar] [CrossRef] [PubMed]
- Baranowska-Wójcik, E.; Szwajgier, D.; Oleszczuk, P.; Winiarska-Mieczan, A. Effects of titanium dioxide nanoparticles exposure on human health—A review. Biol. Trace Elem. Res. 2020, 193, 118–129. [Google Scholar] [CrossRef] [PubMed]
- Dastjerdi, R.; Montazer, M. A review on the application of inorganic nano-structured materials in the modification of textiles: Focus on anti-microbial properties. Colloids Surf. B Biointerfaces 2010, 79, 5–18. [Google Scholar] [CrossRef] [PubMed]
- Weiss, J.; Takhistov, P.; McClements, D.J. Functional materials in food nanotechnology. J. Food Sci. 2006, 71, 107–116. [Google Scholar] [CrossRef]
- Rezaei-Zarchi, S.; Javed, A.; Ghani, M.J.; Soufian, S.; Firouzabadi, F.B.; Moghaddam, A.B.; Mirjalili, S.H. Comparative study of antimicrobial activities of TiO2 and CdO nanoparticles against the pathogenic Strain of Escherichia coli. Iran. J. Pathol. 2010, 5, 83–89. [Google Scholar]
- Singaravelu, G.; Arockiamary, J.S.; Ganesh Kumar, V.; Govindaraju, K. A novel extracellular synthesis of monodisperse gold nanoparticles using marine alga, Sargassum wightii Greville. Colloids Surf. B Biointerfaces 2007, 57, 97–101. [Google Scholar] [CrossRef]
- Jones, S.A.; Bowler, P.G.; Walker, M.; Parsons, D. Controlling wound bioburden with a novel silver-containing Hydrofiber dressing. Wound Repair Regen. 2004, 12, 288–294. [Google Scholar] [CrossRef] [PubMed]
- Ovais, M.; Khalil, A.T.; Ayaz, M.; Ahmad, I.; Nethi, S.K.; Mukherjee, S. Biosynthesis of Metal Nanoparticles via Microbial Enzymes: A Mechanistic Approach. Int. J. Mol. Sci. 2018, 19, 4100. [Google Scholar] [CrossRef] [PubMed]
- Saim, A.K.; Kumah, F.N.; Oppong, M.N. Extracellular and intracellular synthesis of gold and silver nanoparticles by living plants: A review. Nanotechnol. Environ. Eng. 2021, 6, 1. [Google Scholar] [CrossRef]
- Alsaiari, N.S.; Alzahrani, F.M.; Amari, A.; Osman, H.; Harharah, H.N.; Elboughdiri, N.; Tahoon, M.A. Plant and Microbial Approaches as Green Methods for the Synthesis of Nanomaterials: Synthesis, Applications, and Future Perspectives. Molecules 2023, 28, 463. [Google Scholar] [CrossRef] [PubMed]
- Barbinta-Patrascu, M.-E.; Chilom, C.; Nichita, C.; Zgura, I.; Iftimie, S.; Antohe, S. Biophysical insights on Jack bean urease in the presence of silver chloride phytonanoparticles generated from Mentha piperita L. leaves. Rom. Rep. Phys. 2022, 74, 605. [Google Scholar]
- Barbinta-Patrascu, M.-E.; Nichita, C.; Bita, B.; Antohe, S. Biocomposite Materials Derived from Andropogon halepensis—Eco-design and Biophysical Evaluation. Materials 2024, 17, 1225. [Google Scholar] [CrossRef] [PubMed]
- Zgura, I.; Badea, N.; Enculescu, M.; Maraloiu, V.-A.; Ungureanu, C.; Barbinta-Patrascu, M.-E. Burdock-Derived Composites Based on Biogenic Gold, Silver Chloride and Zinc Oxide Particles as Green Multifunctional Platforms for Biomedical Applications and Environmental Protection. Materials 2023, 16, 1153. [Google Scholar] [CrossRef] [PubMed]
- Pillai, R.R.; Sreelekshmi, P.B.; Meera, A.P.; Thomas, S. Biosynthesized iron oxide nanoparticles: Cytotoxic evaluation against human colorectal cancer cell lines. Mater. Today Proc. 2022, 50, 187–195. [Google Scholar] [CrossRef]
- Buarki, F.; AbuHassan, H.; Al Hannan, F.; Henari, F.Z. Green Synthesis of Iron Oxide Nanoparticles Using Hibiscus rosa sinensis Flowers and Their Antibacterial Activity. J. Nanotechnol. 2022, 2022, 5474645. [Google Scholar] [CrossRef]
- Perveen, S.; Nadeem, R.; ur Rehman, S.; Afzal, N.; Anjum, S.; Noreen, S.; Saeed, R.; Amami, M.; Al-Mijalli, S.H.; Iqbal, M. Green synthesis of iron (Fe) nanoparticles using Plumeria obtusa extract as a reducing and stabilizing agent: Antimicrobial, antioxidant and biocompatibility studies. Arab. J. Chem. 2022, 15, 103764. [Google Scholar] [CrossRef]
- Rajamma, R.; Gopalakrishnan Nair, S.; Abdul Khadar, F.; Baskaran, B. Antibacterial and anticancer activity of biosynthesised CuO nanoparticles. IET Nanobiotechnol. 2020, 14, 833–838. [Google Scholar] [CrossRef] [PubMed]
- Alshammari, S.O.; Mahmoud, S.Y.; Farrag, E.S. Synthesis of Green Copper Nanoparticles Using Medicinal Plant Krameria sp. Root Extract and Its Applications. Molecules 2023, 28, 4629. [Google Scholar] [CrossRef] [PubMed]
- Mutalik, C.; Nivedita; Sneka, C.; Krisnawati, D.I.; Yougbaré, S.; Hsu, C.-C.; Kuo, T.-R. Zebrafish Insights into Nanomaterial Toxicity: A Focused Exploration on Metallic, Metal Oxide, Semiconductor, and Mixed-Metal Nanoparticles. Int. J. Mol. Sci. 2024, 25, 1926. [Google Scholar] [CrossRef]
- Sargazi, S.; Laraib, U.; Er, S.; Rahdar, A.; Hassanisaadi, M.; Zafar, M.N.; Díez-Pascual, A.M.; Bilal, M. Application of Green Gold Nanoparticles in Cancer Therapy and Diagnosis. Nanomaterials 2022, 12, 1102. [Google Scholar] [CrossRef] [PubMed]
- Ko, W.-C.; Wang, S.-J.; Hsiao, C.-Y.; Hung, C.-T.; Hsu, Y.-J.; Chang, D.-C.; Hung, C.-F. Pharmacological Role of Functionalized Gold Nanoparticles in Disease Applications. Molecules 2022, 27, 1551. [Google Scholar] [CrossRef]
- Kalashgrani, M.Y.; Javanmardi, N. Multifunctional Gold nanoparticle: As novel agents for cancer treatment. Adv. Appl. NanoBio-Technol. 2022, 3, 1–6. [Google Scholar] [CrossRef] [PubMed]
- Milan, J.; Niemczyk, K.; Kus-Liśkiewicz, M. Treasure on the Earth—Gold Nanoparticles and Their Biomedical Applications. Materials 2022, 15, 3355. [Google Scholar] [CrossRef] [PubMed]
- Nasiri, S.; Mahmoudvand, H.; Shakibaei, M.; Mousavi, S.A.H.; Sepahvand, A. Antifungal effects of zinc nanoparticles green synthesized by Lavandula angustifolia extract, alone and combined with nystatin against Candida albicans, a major cause of oral candidiasis. J. HerbMed Pharmacol. 2022, 11, 540–545. [Google Scholar] [CrossRef]
- Vinodhini, S.; Vithiya, B.S.M.; Prasad, T.A.A. Green synthesis of palladium nanoparticles using aqueous plant extracts and its biomedical applications. J. King Saud Univ.-Sci. 2022, 34, 102017. [Google Scholar] [CrossRef]
- Chen, Y.; Chen, Z.; Yang, D.; Zhu, L.; Liang, Z.; Pang, Y.; Zhou, L. Novel Microbial Palladium Nanoparticles with a High Photothermal Effect for Antibacterial Applications. ACS Omega 2022, 8, 1534–1541. [Google Scholar] [CrossRef] [PubMed]
- Alinaghi, M.; Mokarram, P.; Ahmadi, M.; Bozorg-ghalati, F. Biosynthesis of palladium, platinum, and their bimetallic nanoparticles using rosemary and ginseng herbal plants: Evaluation of anticancer activity. Sci. Rep. 2024, 14, 5798. [Google Scholar] [CrossRef] [PubMed]
- Ullah, A.; Mu, J.; Wang, F.; Chan, M.W.H.; Yin, X.; Liao, Y.; Mirani, Z.A.; Sebt-E-Hassan, S.; Aslam, S.; Naveed, M.; et al. Biogenic Selenium Nanoparticles and Their Anticancer Effects Pertaining to Probiotic Bacteria-A Review. Antioxidants 2022, 11, 1916. [Google Scholar] [CrossRef] [PubMed]
- BenithaJ, G.; Gheena, S.; Ramani, P.; Kumar, R.; Ramalingam, K.; Ramasubramaniam, A. Anticancer activity of Green synthesized selenium nanoparticles from Garcinia Mangostana Crude extract against MCF-7 Breast cancer cells. J. Popul. Ther. Clin. Pharmacol. 2023, 30, 74–82. [Google Scholar] [CrossRef]
- Nagalingam, M.; Rajeshkumar, S.; Balu, S.K.; Tharani, M.; Arunachalam, K. Anticancer and antioxidant activity of Morinda citrifolia leaf mediated selenium nanoparticles. J. Nanomater. 2022, 2022, 2155772. [Google Scholar] [CrossRef]
- Li, C.-W.; Li, L.-L.; Chen, S.; Zhang, J.-X.; Lu, W.-L. Antioxidant Nanotherapies for the Treatment of Inflammatory Diseases. Front. Bioeng. Biotechnol. 2020, 8, 200. [Google Scholar] [CrossRef]
- Abed, A.; Derakhshan, M.; Karimi, M.; Shirazinia, M.; Mahjoubin-Tehran, M.; Homayonfal, M.; Hamblin, M.R.; Mirzaei, S.A.; Soleimanpour, H.; Dehghani, S.; et al. Platinum Nanoparticles in Biomedicine: Preparation, Anti-Cancer Activity, and Drug Delivery Vehicles. Front. Pharmacol. 2022, 13, 797804. [Google Scholar] [CrossRef] [PubMed]
- Vu, C.M.; Ghotekar, S.; Pham, T.D.; Viet, N.M.; Oza, R.; Bilal, M.; Roy, A. Plant-mediated eco-friendly synthesis of platinum nanoparticles and their applications. In Plant and Nanoparticles; Springer Nature: Singapore, 2022; pp. 155–170. [Google Scholar]

| Active Principle Loaded in Nanomicelles | Applications | References |
|---|---|---|
| Casein nanomicelles | Nutraceutics, pharmaceutics, and cosmetics | [23,24,25] |
| Cholesteryl succinyl silane nanomicelles with doxorubicin and gold nanoshells | Cancer therapy | [26,27] |
| Polyplex nanomicelles | CNS therapeutics, Muscle-Targeted mRNA Delivery | [28,29,30] |
| Indisulam stabilized in DSPE-PEG2000 micelles + PC | Cancer therapy | [31,32,33] |
| Cyclosporine A containing nanomicelles using a polyvinyl caprolactam-polyvinyl acetate-polyethylene glycol (PVCL-PVA-PEG) graft copolymer | Topical delivery system for ocular administration | [34,35,36,37] |
| Curcumin nanomicelles | Asthenoteratozoospermia therapy, recurrent aphthous stomatitis treatment | [38,39,40] |
| Silymarin, soluplus nanomicelles with d-α-tocopherol polyethylene glycol 1000 succinate | Antioxidant therapeutics | [41,42] |
| β-carotene-loaded chitosan-graft-poly(lactide) nanomicelles | Functional food, cosmetics, and antioxidant therapeutics | [43,44] |
| Resveratrol-loaded amphiphilic bioconjugate nanomicelles | Colorectal cancer therapeutics | [45,46] |
| Celastrol-loaded nanomicelles | Corneal neovascularization therapeutics | [47,48] |
| MNPs/MO NPs | Bioactivity/Bio-Applications | References |
|---|---|---|
| Fe2O3NPs | Cancer imaging and treatment, antimicrobial and antioxidant activities | [108,109,110] |
| CuO NPs | Antimicrobial, anticancer, antioxidant, anti-inflammatory, and antidiabetic activities | [111,112,113] |
| AuNPs | Cancer diagnosis, PDT, PTT, gene/drug delivery systems, and antiviral and antimicrobial agents | [113,114,115,116,117] |
| ZnO NPs | Antimicrobial and anticancer agents | [77,118] |
| PdNPs | Photothermal therapy, antimicrobial, antioxidant, antidiabetic, and anticancer therapy | [119,120,121] |
| SeNPs | Supplementation, immunostimulatory effect in cancer therapies; anticancer and antioxidant activities | [122,123,124] |
| PtNPs | ROS scavenger, neuroprotective effects, anti-colitis agent, powerful antioxidant, drug/gene delivery, and cancer therapy | [85,86,125,126,127,128,129] |
| CeO2 NPs | Antioxidant activity, multiple sclerosis therapeutic, and wound healing agent | [130,131,132,133,134] |
| TiO2 NPs | Antibacterial effect, PDT, and drug delivery | [135,136,137] |
| AgNPs | Antimicrobial, anticancer and anti-inflammatory activity, drug delivery, tissue regeneration, and healthcare products | [138,139,140,141] |
Disclaimer/Publisher’s Note: The statements, opinions and data contained in all publications are solely those of the individual author(s) and contributor(s) and not of MDPI and/or the editor(s). MDPI and/or the editor(s) disclaim responsibility for any injury to people or property resulting from any ideas, methods, instructions or products referred to in the content. |
© 2024 by the authors. Licensee MDPI, Basel, Switzerland. This article is an open access article distributed under the terms and conditions of the Creative Commons Attribution (CC BY) license (https://creativecommons.org/licenses/by/4.0/).
Share and Cite
Petrovic, S.; Bita, B.; Barbinta-Patrascu, M.-E. Nanoformulations in Pharmaceutical and Biomedical Applications: Green Perspectives. Int. J. Mol. Sci. 2024, 25, 5842. https://doi.org/10.3390/ijms25115842
Petrovic S, Bita B, Barbinta-Patrascu M-E. Nanoformulations in Pharmaceutical and Biomedical Applications: Green Perspectives. International Journal of Molecular Sciences. 2024; 25(11):5842. https://doi.org/10.3390/ijms25115842
Chicago/Turabian StylePetrovic, Sanja, Bogdan Bita, and Marcela-Elisabeta Barbinta-Patrascu. 2024. "Nanoformulations in Pharmaceutical and Biomedical Applications: Green Perspectives" International Journal of Molecular Sciences 25, no. 11: 5842. https://doi.org/10.3390/ijms25115842
APA StylePetrovic, S., Bita, B., & Barbinta-Patrascu, M.-E. (2024). Nanoformulations in Pharmaceutical and Biomedical Applications: Green Perspectives. International Journal of Molecular Sciences, 25(11), 5842. https://doi.org/10.3390/ijms25115842

